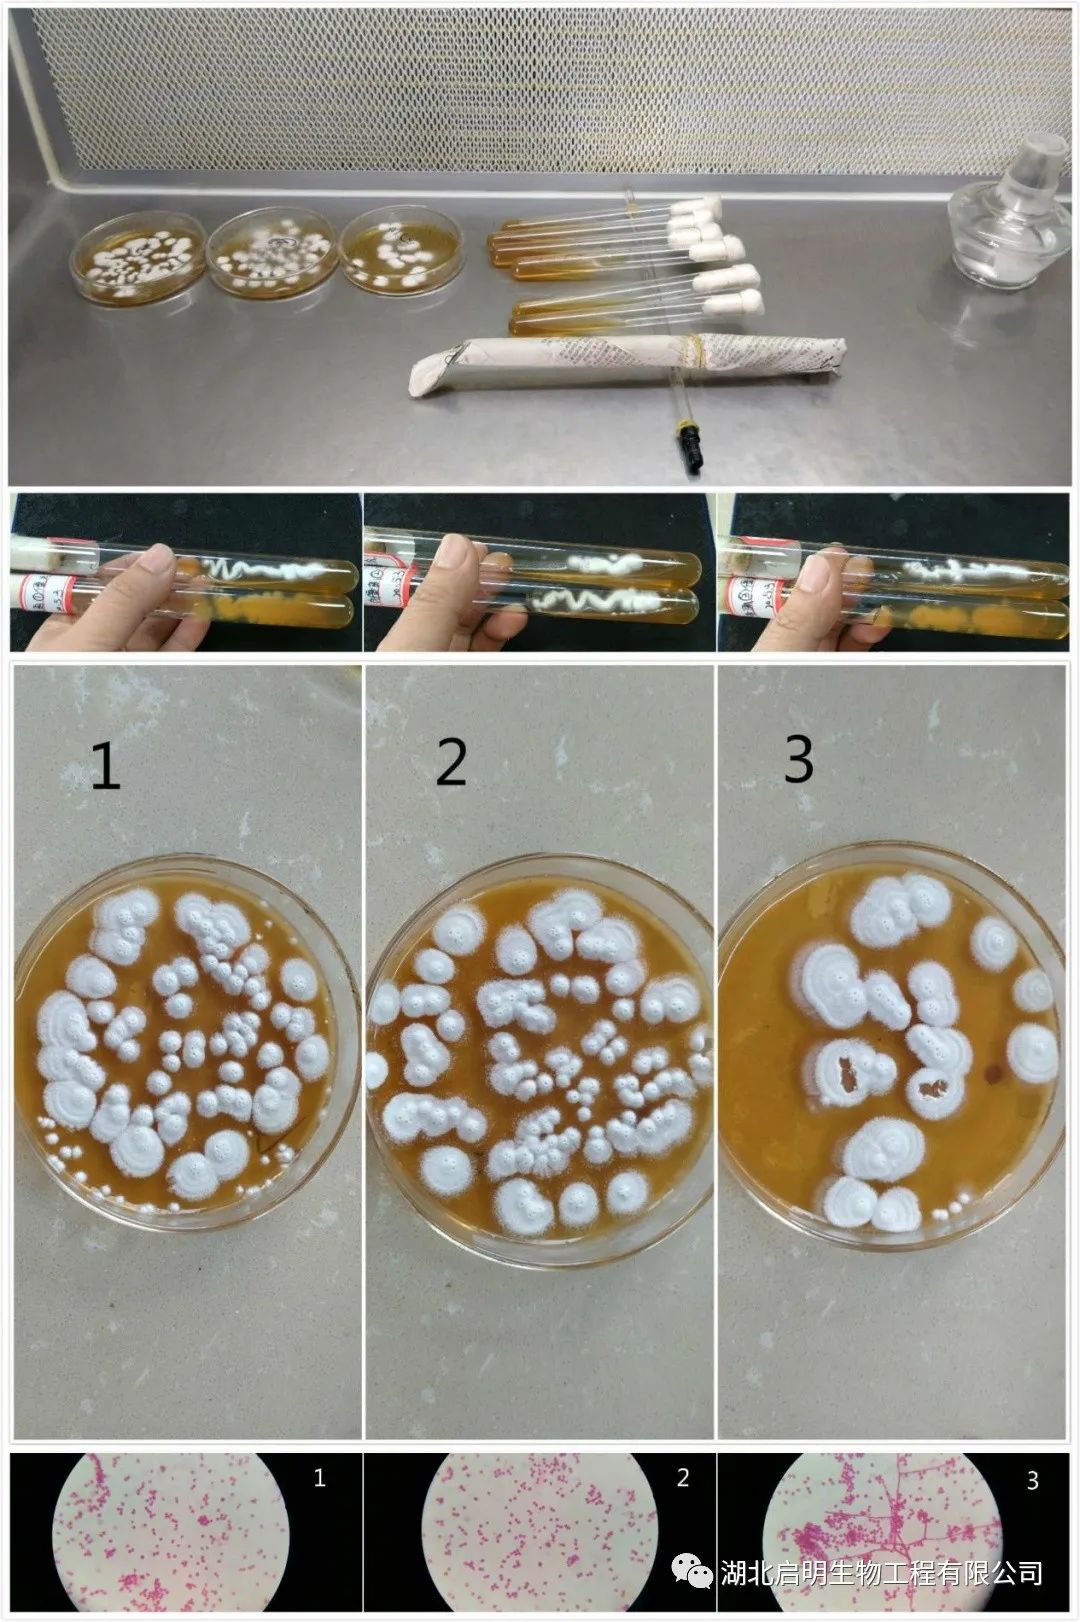

- 當(dāng)前位置:主頁(yè) > 技術(shù)知識(shí) > 產(chǎn)品說(shuō)明 >
- 固體發(fā)酵微生物菌劑原料知名生產(chǎn)企業(yè)
KNOWLEDGE
技術(shù)知識(shí)
球孢白僵菌的復(fù)壯

- 在線咨詢
- 在線留言
- 索要報(bào)價(jià)
- 掃一掃
掃一掃
進(jìn)入手機(jī)網(wǎng)站服務(wù)熱線
0717-4824660 - 返回頂部
KNOWLEDGE
技術(shù)知識(shí)
掃一掃
進(jìn)入手機(jī)網(wǎng)站
服務(wù)熱線
0717-4824660
| 欧美日韩国产一区二区三区| 黄片免费视频软件下载| 2025年最新流行的毛片| 黄色欧美视频一区二区| 欧美一区二区三区伊人| 欧美日本一区二区红桃| 国产成人精品成熟一区| 香蕉在线影一区二区| 欧美熟女啪啪一区二区| 苍井空AV字幕无码| 亚洲性爱欧美天堂一区二区| 欧美大屁股熟妇一区二区| 国产午座精品一区在钱| 欧美一区二区三区淫乱游戏| 香蕉久久aⅴ一区二区三区| 欧美社区一区二区三区| 翔田千里珍藏版无码| 欧美一区二区三区四区五区〖网:.〗| 涩涩视频网站app下载| 欧美成人一二三区伦子| 亚洲天堂香蕉伊人卡一码| 麻豆传媒,视频入口| 精品人妻人妻人一区二区有限公司| 殴美熟女一区二区三区| 麻豆视传媒短视频网站-入口2021仙踪林| 阿av综合1区2区不卡| 欧美国精产品一二区| 神马达达兔亚洲人一二三区| 精品一区欧美激情| 色窝窝线视频在线观看| 熟女人妻一区二区三区四区在线看 | 蜜桃一区久久久久| 20251009亚洲无码| 欧美日韩国产综合一区二区| 渴望茱莉亚-性色av色香蕉一区二区三区-成人AV | 欧美综合一区二区三区手机版| 欧美白人一区二区三区| 殴欧美亚一区二区三区| 综合欧美一区二区成人生活片| 欧美日韩一区二区三区赢当| 男生露yj露睾丸网站| 韩国v66av无码片| 国产精品中字一区二区| 欧美日韩一区二区在线播放| 黄色内射一区二区三区| 枫富爱Av一区二区三区中文字幕| 欧美日韩黄色电影下载| 竹菊传媒一区二区三区| 欧美成人r一区二区三区| 欧美成人精品a一区二区| 特黄特色大片免费观看播放器| 麻豆天美糖心一区二区 | 黄色片成人网站免费| 欧美一区二区三区综合色| 亚洲成年精品一区.| 美女黄视频软件免费下载| 国产成人在线tube| 精品国产一区二区三区天美传媒 | 欧美日韩精品一区二区香蕉下载| 亚洲影视欧美一区二区| 色色资源免费服务平台欧美性爱三区 | 色窝窝视频在线播放| 精品国际一区二区三区欧美| 来个免费的黄色网址| 色狠狠综合一区二区| 视频一区视频二区欧美| 欧美第一区在线观看视频| 自慰一区二区三区欧美| 欧美强黄色一区二区| 国产欧美一区二区三区色情| 韩国一区二区三区在线观看| 欧美黄片一区二区三区| 国产欧美1区2区3| 欧美大黄一级片免费的| 蜜桃综合久久一区二区| 欧美国产精品第一区第二区| 欧美一区,二区,三区的男人们| 国产福利片一区二区| 国产成人+综合+欧美| 重口调教一区二区三区| 欧美大胆一区二区三区| 污污污视频网站在线观看下载| 韩国成人网站漫画无码| 欧美激情视频一区二区在线观看 | 香蕉久久国产Av一区二区| 国产伦一区二区三区免费| 麻豆精品传媒一区二区| 国产一区二区苹果视频| 欧美成人三级小说网| 欧美一区二区三区爱爱| 韩国理论国产一区二区| 欧美非洲一区二区视频| 颤抖小蜜桃成人网站| 美女隐私免费看网站| 殴美日韩一区二区三区不卡| 国产性感主播福利一区二区| 歐美精品一區二區三區四區| 色呦呦在线无限观看| 美女的隐私剖位免费网站| 欧美成综合在线观看| 国产成人精品免费视频大全下载 | 欧美一区二区三区四区五区六七区八| 草榴莲一区二区三区四区| 草榴莲一区二区三区四区| 精品人妻一区二区三区微信 | 亚洲成人看片一区二| 欧美在线精品一区二区三 | 国产伦无码一区二区| 色导航色亚洲一区二区| 欧美曰国产精品一区二区三区| 欧美一区二区三区另类视频| 黑人巨大精品一区二区三区兔费| 欧美在线一二三四五区| 狠狠中文寂墓一区二区| 国产福利片二区| 精品偷拍一区二区三区在下载| 男人又爽又黄免费| 色窝窝无码一区二区| 欧美成人精品一区二区男| 国产微信小视频二区| 综合久久加综合久久| 欧美一区二区三区666古代| 黄片免费视频软件下载| 黄本子视频网站在线看| 非州精品一区二区三区| 福利导航永久地址App下载| 韩日老撸友一区二区| 欧美一区二区三区四区五区无卡码 | 欧美国产日韩一区二区三区粉嫩| 欧美极品白浆一区二区| 欧美影视黄一区二区| 肥屁股欧美一区二区| 欧美一区二区三区四区五区六区七区八区| 杨钰涵欧美一区二区三区| 欧美成人小视频一区| 沈阳熟女白浆一区二区| 欧美性生活一区二区三区四区| 亚洲妓女一区二区三区| 黄网2025最新在线观看| 翔田千里无码破解版| 国产伦精品一区二区妓花| 欧美老熟女亂伦一区二区三区| 欧美大码一二三区免费| 精品区一区二区三四区香蕉| 欧美综合精品良家一区二区| 亚洲成人AV苹果影视| 欧美一区二区三区在线免费| 黄片污版免费在线观看| 美女18禁免费看视频APP| 欧美色老头子一区二区| 欧美国家一区二区久久| 韩国精品无码少妇在线观看网站| 韩国伦理一区二区三区| 永久免费啪啪啪网站| 欧美日另类一区二区| 国产一线二线福利在线| 色婷婷图片视频成人福利| 欧美精品在线一区二区三区| 欧美视频啪啪啪一区二区| 欧美国产精品一区二区| 老司机在线一区二区| 欧美男生射精高潮视频网站| 国产成人网红在线看| 老牛一区二区三区四区| 欧美日韩黄精品一区二区一区二区| 欧美一区二区三区四区精品粉嫩| 色婷婷免费情趣视频| 欧美精品XXⅩ一区| 黄网浏览器在线观看视频| 香港欧美一区二区三区四区在线下载 | 欧美成人视频肥逼一区二区| 黄页网站18以下勿看| 激情国际一区二区三区 | 精品欧美一区二区精品一区| 欧美大码一二区免费| 欧美在线中文字幕在线观看视频免费下载 | 磁力亚洲一区二区三区| 鸥美成人黄色一品区二品区三品区| 网友自拍欧美激情视频区| 欧美激情一区二区在线 | 黄色地址欧美一区二区三区| 男人天堂2025手机在线免费观看| 欧美一区二区三区成践| 国产又爽又黄免费下载| 男人天堂2025手机在线免费观看| 亚洲成人网站下载观看| 色色网战免费下载双飞| 欧美成人亚洲一区二区| 韩国久久久久久久久久久久日 | 欧美大屁股一区二区三区| 蜜桃永久视频在线一区二区三区| 欧美综合精品良家一区二区| 欧美成人线路一线路二| 蜜桃精品久久久一区二区| 欧美成人桃红在线一品二品| 亚洲媚药一区二区三区最新| 精品乱子伦一区二区三区下载| 亚洲成人aaa1区二区| 美女的隐私部位网站| 亚洲成年精品一区.| 美国一区二区无视频| 亚洲嫩模一区二区三区 | 色婷婷丁香五月综合| 亚洲成色在线综合网| 精品日韩欧美久久深夜福利 | 本田岬人妻在线一区二区| 欧美达一区,二区,三区,特黄| 国产精品一区二区综合| 特黄特色大片视频免费播放软件 | 国产伦一区二区三区免费| 蜜桃国内精品久久久久软件| 欧美情一区二区三区| 美国欧洲视频xxxApp下载| 国产欧美一区二区三区四区| 欧美经典精品一区二区| 色小孩影院欧美一区| 色噜噜AV***一区二区| 亚洲无码,精品一区| 香蕉久热一区二区三区| 欧美性爱网一,二,三区| 艾娃亚当斯一区二区三区最新消息视 | 深夜福利亚洲一区二区三区 | 男女做爱免费app| 国产专职小姐一区二区| 欧美日韩视频一区二区| 红豆视频一区二区三区| 欧美强坚一区二区三区| 国产日韩精品一区二区三区软件| 欧美视频图片小说一区二区| 苹果午夜激情福利视频| 2025久久国产精品网址https://| 网站www你懂我意思吧 | 欧美一区二区三区一级片| 狂暴强伦轩一区二区| 麻豆一二三区精品软件区别| 亚洲成人在线网站二区| 欧美视频VIDEO一区二区| 道黄电影棋牌1区2区| 欧美一区二区三区四区五区〖网:176.22〗| 熟女极品视频一区二区| 视频在线亚洲一苹果| 国产精品一区二区色综合 | 欧美在线啪啪啪一区| 水蜜桃福利一区二区三区| 欧美。XX二区| 欧美成人偷拍一区二区三区| 殴美在线视频观看一区| 老司机成人视频怎么说| 国产成人+综合+亚洲欧美| 老头添女萌道口视频| 黄网永久app免费在线观看| 欧美大香伊一区二区三区| 页面访问升级一区二区| 2025亚洲天堂网| 欧美成人淫秽破处一区二区| 欧美非洲一区二区视频| 美日韩一区二区三区四区五区六区手机免费 | 国产乱码卡一卡二新区网站| 亚洲日产AV一区二区| 欧美视频一区免费看| 美国粗屌免费一区二区| 韩国乱码卡一卡二卡新区网站| 欧美成人精品A片免费一区网站| 熟女人妻乱一区二区三区视频| 色窝窝无码一区二区三区2022| 国产一区二区三区欧美| 欧美一区二区三区四区五区操逼| 综合久久,综合色蜜桃| 页面正在升级欧美一区| 黑丝一区二区三区,| 国产成人在线播放2025| 亚洲成人第一在线二区| 欧美性爱人兽一区二 | 欧美爱爱一区二区二| 精品人生一区二区三区| 色呦呦在线观看入口| 国产欧美精品一区二区三区| 欧美一区二区三区幼| 欧美在线一二三四五区| 欧美成人一区日二区日| 欧美成人综合一区二区| 欧美激情四射一区二区| 欧美熟妇精品一二三区| 色婷婷成人做爰A片免费看网站正常男生是翻出来还是包着我高一躺着拍的大吗 | 极品露脸一区二区蜜桃| 亚洲成人一品成人一品| 欧美成人一二三区一| 欧美日韩亚洲台湾一区二区| 欧美激情一区蜜桃视频| 欧美激情欧美狂野一区| 欧美综合一区,二区视频| 殴美geeexx一二三区| 歐美一區二區三區在綫視頻| 污视频成人网站免费下载 | 欧美精品一区二区都可以| 欧美自慰无码一区二区下载| 殴美性爱视频一区二区| 欧美高清砖码一二区| 污污污视频网站免费| 涩涩网站在线免费下载| 麻豆精产国品一二三产品何苗| 国产又爽又黄免费| 欧美一区二区三区四区五区〖网:.〗| 欧美男同国产一区二区| 欧美色欧美亚洲另类二区蜜臀| 欧美高清一区二区三区四区| 欧美精品在一区二区| 欧美精品欧美一区二区三区 | 欧美一区二区三区不免费| 国产欧美视频不卡一区二区 | 鲁大师一区二区三区| 麻花豆传媒mv在线观看网站| 非洲熟悉精品一区二区三区| 色成人网站在线免费抖音ww| 黄网站免费永久在线观看下载| 黄色.comwww| 视频一区二区中文欧美字幕| 美女黄色18无下载| 男人的天堂在线观看2025| 海角社区在线免费观看视频| 欧美系列一区二区女秘书| 老司机深夜开车一区二区三区| 精品一区二区三区浪潮| 爆乳hitomi亚洲一区二区| 麻豆文化传播媒体入口| 桃色成人在线亚洲一区| 超碰亚洲欧美,日本一区二区三区| 让客户达到高峰的社长秘书空姐一区| 里崎爱佳一区二区三区| 美国大香蕉久久久久久久久久久 | 黑人巨大精品欧美一区二区免费 | 欧美激情一区蜜桃视频| 亚洲天堂成人在线社区| 国产成人短视频观看| 香港欧美一区二区三区四区资源下载 | 欧美日韩高清一本道| 亚洲成人一期二期三期| 欧美综合精品良家一区二区| 欧美国产美女性爱一区二区| 色情欧美人妻一区二区下载视频| 欧美一区三区三区高清不卡 | 香澄丽子一区二区三区| 精品欧美区一区二区三区四区| 欧美爱爱一区二区二| 国产精品一区二区推荐| 韩國女主播精品一區二區| 网页升级访问日韩一区| 欧美大鸡吧一区二区| 男女成人app免费观看| 欧美成人桃红在线一品二品| 国产日韩精品欧美2025| 黄色性爱网站在线下载| 亚洲天堂网站APP| 男女不网站2025| 欧美特黄一级一区二区电影| 国产成人精品一区二区| 美女18网站app| 欧美黄色国产一区二区| 蜜桃精品一区二区不卡| 韩国日本一卡二卡3卡4卡网站| 美国成人精品一区二区| 欧美日韩黄精品一区二区一区二区| 欧美一区二区三区四区五区六区| 欧美老阿姨一区二区| 欧美操逼一二区视频| 欧美葡京娱乐大香蕉一| 视频日韩中文字幕制服| 亚洲成成在线app| 欧美性爱一区二区社区| 欧美性爱第一区二区三区| 老司机永久免费在线视频新版| 欧美城人精品一区二区三区| 欧美一区二区三区不免费| 欧美国产精华一区二区三区| 麻豆传媒一区二区三区 | 国产欧美一区二区三区综合野| 殴美一区二区三区享享| 欧美成人精品一区二区免费资源| 欧美一区二区三区不卡黄片| 黄色网一区二区三区| 美女隐私网站在线观看代码 | 欧美一区三区在线专区小说atv| 欧美多人在线一区二区| 欧美精品一区二区不卡| 精品媚药一区二区三区四区 | 欧美日韩一区二区不卡我| 欧美一区二区三区另类视频| 裸美XXX一区二区三区| 国产亚洲欧美激情一区二区| 欧美激情免费一二三四| 国产成人AAAAA| 欧美一二区激情视频| 白白发布免费在线播放视频| 萌白酱精品一区二区| 欧美在线精品二三四区| 艹逼app..com| 黄色网址大全免费版| 越南妓女一区二区三区| 2025国产毛片真人真事| 黄色应用亚洲专区一区二区三区| 色窝窝免费视频网站| 锕锕锕锕锕锕锕~好湿啊| 欧美一区二区三区导航| 精品免费产品日亚韩三区精品| 色妞***一区二区三区四区| 粉屁眼在线一区二区| 欧美视频一区在线观看| 极品销魂一区二区三区的游戏应用 | 欧美精品黑丝管一区二区三区| 熟女做爰一区二区三区| 欧美性爱一区-二区| 亚洲成人网址app大全 | 海角社区在线免费视频| 杨晨晨ThetrnAV一区二区三区| 浴室里强摁做开腿呻吟的更新时间| 美周天堂一区二区三区| 2025av天堂网| 特黄特色免费观看视频| 国产一线二线三线女装品牌| 翔田千里珍藏版无码| 欧美成人精品在线观看下载| 香港日韩凹tu二区三区| 蜜桃香蕉精品一区二区三区| 黄色一级片专收国产果冻传媒开处| 国产一区二区三区中文字幕| 香蕉久久国产一区二区| 2025国产精品免费一区| 韩日一区二区三区四区| 金瓶梅一区二区免费| 淫秽视频下载下载网站| 欧美日韩国产综合剧情一区二区| 美洲天堂一区二卡三卡四卡 | 能免费看的国外最大的成人网站 | 欧美综合色区手机版| 欧美黄色胖子黄色胖子网站专区| 欧美精品在线一区二区三区| 韩日独立站免费欧亚| 欧美精品二区三区四区免费看视频 | 欧美美图小说视频一区二区三区| 欧美一区二区三区啪啪啪啪| 欧美一区二区三区按摩在线| 国产福利一区二区视频| 国产一区二区欧美日韩| 亚洲成人色网站在线| 欧美淫荡妇一区二区| 欧美精品一区二区不卡| 国产真人做爰视频免费看| 国产一区欧美二区mm| 欧美成人精品一区,二区,三区| 欧美精品成人一区二区直挂| 男男免费看,十八禁| 网站你懂我的意思吗免费| 欧美激动一区二区三区| 欧美熟妇高潮一区二区| 欧美独立一区二区三区| 海角视频社区久久 | 豆花视频一区二区三区| 色吧亚洲色欧美色一区二区三区| 国产亚洲精品一区二区一区| 欧美视频中文字幕一区二区 | 狂吻胸视频网站免费观看下载| 亚洲成人免费性情网站| 欧美护士区一区二区| 麻豆传媒在线一级二级| 欧美成人a62v免费视频| 黄色网址大全免费版| 歐美A√9213一区| 欧美一区二区三区成人精,,,,,,,| 高清一区不卡中文字幕| 欧美重口另类女奴一区| 鲁丝一鲁丝二鲁丝三| 香港亚洲非洲三级网站| 欧美色综合1区2区3区| 欧美一区二区三区大屁股| 欧美视频一二三四区| 网页升级访问日韩一区| 老司机三分钟免费体验区| 黑人精品欧美一区二区蜜| 色成人网站在线免费抖音ww| 男人女人裸体,免费下载| 欧美性做爰全过程免费| 欧美床上拍一拍一二区| 国产精品一二区成人| 欧美高清视频一区二区三区| 欧美高清1区2区3区| 视频中文字幕一区二区三区| 黄色冈.com赞AP.comP91| 麻豆文化传播媒体入口| 欧美成人精品一区二区三区 | 韩日二区三区四区不卡顿| 欧美服日韩中文字幕制服| 欧美精品免费A片观看| 韩国黄色无码手机版| 欧美一区二区三区二页| 国产欧美一区二区精品仙草咪平台介绍| 欧美性一曲二曲三曲| 精品人妻无码一区二区三区下 | 国产福利片二区| 青苹果一区二区三区| 亚洲成人网址app大全| 福利视频合集1000| 欧美福利区一区二区文字| 欧美一区二区三区不卡黑人| 神马午夜电影院神马午夜福利| 亚洲成人网站免费看| 锕锕锕锕锕锕锕好大| 黄色在线一区二区三区| 欧美np啊啊啊啊一区| 亚洲无码中文字幕在线免费观看软件 | 亚洲成人aaa1区二区| 欧美熟女一区二区免费| 欧美视频手机在线一区| 鲁大师日本一区二区| 黄色视频免费看网店| 国产,亚洲,欧美一区二区| 2025国产最新无码精品| 欧美、精品,一区,二区| 欧美一区二区三区成人免费 | 亚洲成人电影一区二区| 欧美性激情一区二区| 欧美性交一区二区三区| 欧美性生交XXXX| 亚洲成人免费观看有限责任公司 | 欧美精品一区二区三区综合 | 亚洲天堂视频网苹果| 亚洲成人黄色电影一区二区 | 香蕉久久免费不卡一区| 韩国美女自摸一区二区三区| 超碰成人地址一地址二| 韩国三级一区二区二| 苍井空无码资源下载| 葵司日韩一区二区三区| 欧美一伦一情一色网站| 国产欧美一区二区三区免费| 20251009亚洲无码| 麻逗传媒文化一区二区| 麻斗app官方下载| 欧美幼兽一区二区三区| 亚洲成色在线综合网| 欧美基情一区二区三区| 淫色网网站大全APP下载| 欧美黄色大一区二区| 欧美日韩综合高请一区二区日本一区二区 | 黑大巨大一区二区三区| 麻豆精产国品一二三产品| 麻花豆MV免费视频| 老司机成人精品视频| 综合影音国产一区二区按摩| 牛牛精品一区二区视频| 欧美精品一区二区婷婷| 欧美成人精品一区二区三区免费| 欧美性爱综合一区二区三区| 亚洲成人a**夜店色戒网站-成人AV| 欧美一区二区三区淫乱游戏| 国产欧美日韩综合精| 麻豆传媒,视频入口| 韩日欧美一区二区三区综合蕉| 欧美vr一区二区三区| 青青草色情软件下载| 精品欧美区一区二区三区四区| 黄网站app在线观看撸| 老熟妇欧美高潮一区二区三区| 美女下身被看光网址| 本日无久湾一在区道| 色偷偷男性亚洲一区二区| 韩国高能预警伪娘后入一区二区三区 | 欧美大尺度一区二区| 国产成+人欧美+综合在线观看| 非洲一区二区三区免费| 国产欧美一区二区三区A| 颤抖小蜜桃成人网站| 经典再现一区二区三区| 欧美粗大一区二区三区四区| 欧美国产精品区一区| 国产一区、欧美一区| 美女很黄网站是免费| 欧美色图图片专区一区二区三区传媒 | 精品人妻无码一区二区三区换脸| 欧美黑人一区二区三区久久 | 欧美日韩在线观看一区二区三区在线观看App下载 | 欧美成人精品一区二区三区四区 | 欧美黑人性爱一区二区三区| 熟女温泉不伦一区二区| 狠狠干一区二区三区| 玉蒲团中文字幕一区二区| 欧美熟女性爱一二区| 韩国色老汉一区二区| 色窝窝9797pw| 欧美色图开心激情网| 亚洲成人网站免费观看| 欧美精品一区二区三区四区五区| 网站你懂我的意思吧免费的 | 欧美视频在现一区二区| 欧美性理论一二三区四五区| 香蕉视频一区二区三区| 美女的隐私直接进入免费网址| 欧美精品一区二区视频免费| 老司机成人福利视频| 欧美成人一区二区冫| 黄网视频网站永久免费观看| 精品囯产综合一区二区| 欧美成人电影一区二区的一区 | 男女人裸体性做爰视频| 欧美成人小视频一区| 黑巨人精品一区二区三区丰满| 精品秘一区二三区费雷安| 欧美日韩123区不卡| 高潮激情精品一区二区| 欧美香蕉视频播放一区| 欧美一区二区三区四区五区无卡码| 视频一视频二视频三在线视频| 欧美视频一区在线观看| 国产欧美一区二区三区免费| 福利视频一区二区三区四区五区| 欧美一区二区三区按摩在线| 肌肉佬探花一区二区| 欧美成人电影一区二区的一区| 视频号一区二区视频| 欧美白人极品一区二区三区 | 网站黄在线观看免费| 欧美无人矿一区二区| 韩国女主播在线一区二区三区| 欧美福利一区二区三区| 未遮挡网站+在线观看| 沈阳的48岁熟女视频| 国产一区欧洲一区二区| 亚洲天堂日本社区网| 男女欧美视频一区二区三区| 国产精品区一线二线三线| 男生露jiji秘网站免费下载| 国产成+人综合+亚洲专区| 水野朝阳精品一区二区| 高清1区2区3区4区产品| 欧美特黄aaaaa一区二区| 西西综合一区二区三区| 欧美成人免费下载免费| 美国精品一区二区三区| 亚洲媚药一区二区三区最新| 美女永久免费网站视频成人快手 | 狂野欧美久久一区二区| 黄色欧美在线一区二区三区| 韩国日本欧美视频二区| 欧美大鸡巴一区二区| 精品欧美国产一区二区| 欧美激情成人一区二区| 苹果一区二区三区| 欧美一区二区三区四区视频 | 黄色成人链接网站下载| 欧美水果在线一区二区| 蜜桃综合久久一区二区| 欧美国产福利一区合集| 真人做爰高潮视频试看40分钟| 国产果冻传媒中文原创| 欧美精品一区二区三区一品| 香娇九九九福利导航| 美国一级片软件下载| 2025国产精品免费一区| 欧美精品秘一区二区三区蜜| 蜜芽-mytv188| 亚洲成人欧美一区二区| 毛卡一卡二卡三免费| 页面访问升级一区二区| 欧美性一区二区三区性暴力| 爽妇一区二区三区四区| 欧美影院免费亚洲一区二区| 深夜福利福利网站亚洲一区| 青青操欧美亚一区二区三区四区五区六区熟女 | 2025av无码91| 欧美激情性视频一区二区| 色哟哟全部视频免费观看| 欧美一二三区好看云| 色色网战免费下载双飞| 欧美成人五区不卡免费| 神木丽av无码专区观看| 欧美成人一区二区,| 温泉媚药一区二区三区 | 色窝窝无码一区二区三区软件| 亚洲成人在线综合一区二区| 欧美黄片一区二区三区| 色情网站app视频| 欧买特级黄片一区二区三区| 欧美成人一区二区添逼| 熟女老阿姨一区二区| 欧美女性爱一区二区三区| 殴美成人五级黄色网| 综合激情淫一区二区三区三| 国产zuoai成人| 欧美性爱爱一区二区三区| 深夜美女福利APP免费下载| 美女隐私随便看网站| 黄片网站app免费djdjdh| 香港,台湾高潮不卡,一区,二区,三区。| 欧美在线亚洲一区-咪咕视频最佳磁力引擎磁力天堂 | 欧美精品α级一区二区三区 | 茄子视频一区二区在线观看 | 自由色XXⅩ业余自由视频网下载| 国产成人AAAAA| 男生露jiji秘网站免费| 亚洲成人在线观看免费公司| 欧美狂野视频一区二区| 激情丁香婷婷五月网| 综合久久久久综合综合久…| 辉月あんり亚洲一区二区| 黑人精品一区二区三区| 涨精装满肚子用塞子堵住免费| 色哟哟不卡免费视频| 特美1级aa免费。| 综合久久久久综合综合久…| 色八戒一区二区三区四区五区| 麻豆传媒映画一区二区| 国产精品亚欧美一区二区| 亚洲成色77777| 美女扒开腿秘男人爽桶| 视频中文字幕一区二区三区| 麻豆传媒app网站| 麻豆视传媒短视频网站-入口2021仙踪林 | 高跟一区二区三区四区| 国产欧美一区二区三区高清不卡 | 草逼cccc123456| 非洲人欧洲人社区一区二区| 欧美激情在线视频一区二区| 欧美色色一二三四五六区| 男男被爽到翻白眼| 福利社男女一区二区| 爆乳hitomi亚洲一区二区| 真人做爰高潮视频试看40分钟| 国产成人综合亚洲专区| 国产精品撸一撸一区二区| 国产福利一区二区三区视频| 男人天堂网在线观看| 男人露jiji秘免费视频网站麻豆| 欧美一区二区三区亚洲| 亚洲成人在线综合一区二区| 欧美性生活一区二区三区| 熟女俱乐部一区二区| 神马速一区极速一区| 狼噜噜精品一区二区三区| 熟妇一区二区蜜桃视频| 深夜福利司机一二三四区| 男人网址大家都懂2019| 爱视频一区二区三区| 殴州乱码或亚州乱码| 欧美黄色一区二区三区| 香蕉淫秽视频一区二区三区| 黄偏免费网站daquan| 韩国v66av无码片| 色呦呦呦呦呦呦呦呦呦呦呦 | 色呦呦在线无限观看| 国产日韩高清欧美专区| 麻豆视传媒网站免费入口| 香蕉av一区二区三区| 视频欧美在线一区| 美国黄色视频一区二区三区 | 欧美一区二区三区大屁股撅起来| 欧美一区二区三区一| 黄网站大全安免费黄在线| 黄色片网站现在免费安装| 欧美女一区二区口射精品| 欧美一区二区三区福利| 国产91一区在线观看| 2025国产精品在线一区| 麻豆视传媒适当放松| 青青草app成人看片软件| 草榴莲一区二区三区四区| 美女自慰一区,二区,三区。| 国产精品一区二区三区粉| 国产伦精品一区二区三区男妓| 麻豆明星换脸一区二区| 英美馒头逼不卡一区二区视频| 美女自慰色网下载APP| 熟女露脸一区二区三区| 欧美成人一二区观看| 欧美黄片一区二区3区| 欧美性爱一区二区二| 特黄一区二区三区三州| 欧美综合色区手机版| 精品欧美黑人一区二区三区| 欧美日成人一区一本| 色欲网址App下载| 黄网站在线永久免费观看| 美女网站成人18+| 欧美一区二区三区,操逼视频| 国产精品一二区成人| 国产精品亚洲综一区二区| 国产一区二区三区欧洲| 黑人精品秘一区二区三天美| 毛片TV网站无套内射TV网站| 欧美精品性淫乱片一区=区| 美国成人动漫AV一区二区| 欧美一区二区三区白人| 韩日中文欧美一区| 综合久久加综合久久| 色婷婷在线成人网站| 欧美精品一区二区潮喷| 激情深爱一区二区三区| 歐美一區二區三區在綫視頻 | 综合图区亚洲一区一本| 欧美黄色胖子网站专区| 欧美综合在线一区二区| 美女全黄免费看网站| 国产成人欧美一区中文字幕| 麻豆视传媒网站免费入口| 亚洲天堂无码一区二区| 未满十八免进WWW网站| 欧美特区一区二区三区| 番茄一区二区三区四区| 欧美精品α级一区二区三区| 欧美一区二区三区哚哚| 精品一区二区三区四区五区| 欧美成人电影一区二区的一区| 精品一区二区十八禁蜜桃| 国产海角社区在线观看| 蒂亚在线一区二区三区| 淫岳肥妻一区二区三区| 老熟女一区二区三区| 欧美一区二区三区爽| 欧美激情一区二区三区不卡视频| 欧美国产精品茄子一区| 金瓶梅一区二区免费| 国产一区二区欧美三区| 国产真人做爰视频观看| 国产成人综合电影专区| 熟女亂伦一区二区三区| 亚洲成年人网站免费| 精品一区二区三区欧美人妖| 蜜桃一区二区蜜桃一区| 2024年精品欧美一区二区三区四区| 欧美一区二区三区中文字幕| 亚洲无码不卡大桥未久| 精品亚洲欧美成人一区二区| 欧美新欢电影一二区| 蓝导航在线一区二区| 精品一区二区中文字幕| 欧美成人社一区二区| 黑人一区二区三区精品| 精品人妻无码一区二区三区换脸| 自拍视频一区视频二区 | 欧美性生交XXXXXBBBBB| 黄片App下载污欧美| 男同十八禁网站入口| 欧美成人三区二区一区| 秋霞欧美一区二区三区| 电影一区中文字幕| 精品一区、二区、三网站| 色窝窝无码一区二区| 欧美煌瑟网站久久一区下载| 2025国产一区二区| 欧美一区二区三区二页| 国产欧美精品一区二区免费 | 男人天堂2025手机在线| 亚洲愉拍一区二区三区| 香蕉成人视频网站下载| 欧美成人无码一区二区三区| 真刀实枪一区二区| 欧美成人线路一线路二| 欧美成人艳片一区二区| 黄色软件一区二区在线观看| 欧美一区二区三区幼| 老妈日本老奶一区二区| 欧美性巨大一区二区| 欧美成人精品a一区二区| 超频在线青青草视频| 欧美精品一区二区三区亚裔| 未满十八岁勿入网站WWW_| 超碰天天日一区二区| 欧美成人综合中文网| 色老头国产精品视频| 美国日本精品一区二区| 欧美成人精品专区免费| 韩国羞羞漫画在线观看| 欧美特级黄色一级网络| 鲁大师精品一区二区无码| 欧美精品一区二区三| 国产传媒果冻天美传媒一区2区三区 | 亚洲成人资源综合网| 美国一级黄片一区二区| 高端精品国产探花| 黄色录像视频下载末满18勿进| 欧美特级黄片一区二区三区| 欧美成人一二三四区| 色婷婷成人免费视频网站| 欧美白狐一区二区三区| 麻豆视频回家一区二区| 色资源欧美三区六区百度网盘| 欧美性爱成人-区二区| 老头天堂黄色视频网站| 国产欧美二区五六区| 爽歪歪一区二区三区四区五区| 欧美无砖一中文字目复| 超碰总站青青草一区二区| 谷露影院熟妇人妻一区二区| 美国一区三区二区视频| 欧美一区二区三区色呦呦| 风流老俗女一区二区| 经典再现一区二区三区| 国产欧精品一区二区三区| 欧美精品1区2区3区| 蜜桃一区久久久久| 精品一区二区三区亚洲有限公司| 国产日韩欧美一区精品苹果| 爆乳一区亚洲大奶| 殴亚乱色熟一区二区三四区| 欧美日本韩国小电影下载。| 亚洲成人色穴一区二区| 色婷婷网址最新在线| 欧美在线一区二区三区| 福利500免费导航| 未满十八免进WWW网站| 欧美成功一区二区三区| 肉博团两个女人的高潮| 欧美激情一区二区平| 精品免费产品2023最新| 国产福利精品一区二区三区| 香蕉一区二区三区大区| 欧美激情戏一区二区三区四区五区| 青青草app色版网站iso| 国产欧美精品一区二区三区APP| 殴美一区二区三区视频| 色欲综合欧美一区二区三区| 国产亚洲一卡2卡3卡4卡网站| 欧美激情一区二区精品| 真人无码国产性教育片mp4| 麻豆精品无人区码一二三区别拳交| 欧美调教论坛一区二区| 欧美成人精品A片免费区 | 欧美特级黄色一级网络| 亚洲成年精品一区.| 美股直线跳水欧美成人一区二区| 视频在线一区二区欧美博| 欧美视频一区在线观看一区| 欧美男生射精网站亚洲午夜久久久久| 欧美激情视频在线观看猛男网免费播放网站下载 | 网站晚上你懂2019软件下载| 国产精品一区二区三区粉| 欧美都市激情一区二区三区 | 欧美日韩中文一区二区三区四区五区| 殴美熟女一区二区三区| 蜜桃诱惑肥臀主播一区| 锕锕锕锕锕好大好湿好污 | 欧美国产欧美一区二区| 欧美精品一区二区三区四区五区六区七区| 韩欧美视频在线一区| 老寡妇日韩一区二区三区| 白色jK狂密网站| 青青免费视频下载方法 | 欧美日韩一区二区迅雷| 亚洲成人视频,播放器| 欧美超乳污片一区二区| 精品一曲二曲三曲四曲五曲区| 高清无码外国一级一区二区| 黄网站免费下载观看| 亚洲成人一区、二区| 精品日韩一区二区三区四区游戏| 韩国在线一区二区三区| 色传媒一区二区三区| 美女黄18以下禁止观看无毒不卡| 美洲天堂一区二卡三卡四卡| 色资源欧美三区六区百度网盘| 香蕉久久aⅴ一区二区三区| 亚洲女神福利一区二区| 国产欧美一区二区三区色情| 国产成人欧美一区二区三区八 | 精品一区国产综合| 国产成人精品一二三区| 欧美一区二区三区性| 欧美色图片一区二区| 黄网永久app免费在线观看| 欧美孕妇高潮一区二区| 2024亚洲天堂网| 欧美国产精华一区二区三区| 韩国一区二区三区丫头| 欧美一区,二区免费在线成人| 欧美系列一区二区色色| 欧美日韩亚洲一区二区| 欧美日韩国产精品一区二区| 欧美强奸一二三四网站| 亚洲成人黄色电影一区二区| 国产一区二区成人撸视界| 欧美视频在线观看免费一区| 欧美日韩亚洲一区二区蜜| 相泽南二区三区下载| 色逼看的软件成人快手| 青青免费老司机视频| 亚洲天堂欧美视频区| 欧美日韩卡一卡二在线播放视频| 视频号一区二区视频| 黑人AV一区二区三区| 欧美成人乱码一区二区三区| 欧美一区二区中文视频| 欧美熟女性爱另类一区| 亚洲天堂最新免费视频| 麻豆传文化传媒网站入口免费| 国产日韩欧美一区精品苹果| 精品亲子乱一区二区三区 | 柠檬导航一区二区三区| 欧美精品一区二区三区14p| 国产伦一区二区三区四区| 深夜美女福利APP免费下载| 欧美一区二区三区在线激情| 蜜桃一区二区红粉影楼| 欧美色综合1区2区3区| 精品线路一区二区| 欧美黑白大战一区二区三区| 清纯唯美亚洲欧美中文一区三区四区 | 欧美经典精品一区二区| 色呦呦视频seyouyou?| 精品欧美成人一区二区| 欧美水果在线一区二区| 国产偷窥猎奇福利二区| 神木丽无码一二三区在线观看| 综合色图一区二区不卡| 欧美精品免费一区二区三区| 欧美日一区二区三区| 欧美成人视频一二区三区| 黄片App下载污欧美| 蜜桃成人无码区免费视频网站| 超碰香蕉一区二区三区| 欧美激情视频第一区| 欧美一区二区三区精品| 欧美一区二区www| 欧美护士区一区二区| 蜜桃久久就成熟日日| 红杏污欧美成人一区| 精品线路一区二区| 欧美成人电影一二三区| 欧美一区二区三区不免费| 欧美高清5KAV一区不卡| 蜜桃网欧美精品一区二区| 精彩亚洲一区二区三区四区| 欧美成人一区二区二区| 韩国理论国产一区二区| 色综合最新地址是多少| 欧美成人无码一二三区| 黑人黄色一区二区三区| 老司机黄色成人app视频| 国产专区,亚洲一区| 国产成人综合亚洲| 歐美A√9213一区| 视频一区视频二区欧美人妻 | 美女露乳头100%无遮挡| 欧美一区三区精品无卡| 精品亚州调教区二区三区| 麻豆适当的放松一下| 洋土豪米糕一区二区三区| 欧美曰国产精品一区二区三区| 欧美极度虐待一区二区| 欧美成人黄片网站,免费| 欧美一区二区三区的啪啪| 2025成人地址你懂得| 香蕉免费日本一区二区三区| 欧美日韩一区二区三区| 樱桃码一区二区三区| 欧美韩精品一区二区三区网站下载| 欧美一区二区三bbbb| 自慰一区二区三区无码| 黑人精品欧美一区二区蜜| 欧美日韩熟女一区二区| 欧美特黄一区二区韩国| 精品午夜福利码一区二区| 欧美字幕一二三四五区| 亚洲成人精品成人一区| 米奇亚洲伦理推油一区二区三区 | 国产欧美日韩一区二区三区四区| 欧美精品一区二区在线观看| 色老头在线免费视频| 熟女俱乐部一区二区| 亚洲成人黄片一区二区三区| 欧美综合乱伦一区二区| 欧美成人综合一区二区三区| 美女视频黄网站在线观看视频| 欧美情色1区2区3区| 黑人巨大精品一区二区三区兔费| 欧美激情无码一区二区| 青青草APP污污污免费下载苹果| 深夜福利在线二区三区| 国产无人区卡一卡二卡三网站| 男人天堂网2020| 欧美激情一区二区三区黑呆 | 欧美激情一区二区三区亚洲视频声音太大 | 黄网站app在线观看撸| 男人露jiji秘免费视频樱花| 欧一美一色一伦一区二区三区| 欧美精品一区二区三区四区五区| 欧美成人性生活,一区二区| 欧美精品一区二区三区三区 | 亚洲成人性爱一区二区| 欧美日韩国产精品2025| 亚洲性爱一区天美传媒| 亚洲成人色穴一区二区| 欧美日本成人电影一区| 精品一区二区三区老逼| 国产一区二区中文字幕| 欧美一区二区三区的区| 欧美黄色操b一二三区| 欧美一区二区三区激情啪啪| 欧美精品一区二区福利电影| 欧美成人二区三区三区| 欧美老狼人一区二区三区| 真人免费视频做成A片| 香蕉久久AV一区二区三区| 欧美色图在线小说一区二区| 欧美精品一区二区三区四区| 欧美色区,一区二区三区| 亚洲天堂网站上课了| 亚洲成人亚洲一区中文字幕| 欧美精品一区二区三区亚裔| 韩国演艺圈卡一卡二新区| 国产精品一区二三区三亚| 黑人精品X一区二区三区| 男人天堂网自拍视频| 欧美老妇人一区二区| 亚洲无人精品一区二区| 蜜桃AV成人永久免费| 法国精品精品一区二区| 欧美精品高清免费一二三区| 国产欧美黄乱绿一区二区三区| 精品一区二区三区三州小圈| 牛牛精品一区二区三区。。。。 | 欧美日成人一二三区| 亚洲天堂无码一区二区三区| 蜜桃传媒一区二区三区| 欧美成人久久久一区| 荷兰双飞一区二区三区| 亚洲成人下载免费观看| 福利亚洲100000| 韩日一区二区三区中文字幕| 男人天堂DVD国产直播| 黄网站色成年大片免费高| 欧美精品一区二区久| 豆豆色成人免费视频在| 欧美美图小说视频一区二区三区| 黄色电影18wwwwwwwwwwwwwwwwwwwwwwwwwwwwwwwwwwwwwwwwwwwwwwwwwwwwwwwwwww | 激情综合丁香婷婷色五月| 国产又爽又黄A片免费观看| 欧美精品在欧美一区二区| 狼噜噜精品一区二区三区| 黄页网站18以下勿看| 欧美日韩直播视频在线播放二区 | 亚洲成人观看APP下载网址| 粉嫩高清一区二区三区天美| 欧美日韩精品一二区| 精品人伦一区二区三区闺蜜| 国产成人兼职视频在线播放 | 欧美黑人性爱一区二区三区| 高清亚洲欧美视频一区二区| 青青草破解版成人视频软件| 欧美在线一区二区影院| 独家精选福利二区| 欧美性交农村一区二区| 国产欧美婬乱一区二区| 欧美成人精品区网站| 非州精品一区二区三区| 欧美大码一区二区免费| 电影亚洲人成在线看| 韩日欧美一区二区三区综合蕉| 亚洲成人2区在线| 欧美精品一区二区在线| 国产精品2025久久| 亚洲无码APP下载| 欧美短视频精品二区| 窝窝社区www成人版| 麻豆星空传媒一区二区| 欧美一区二区三区四区五区久久 | 牛牛精品视频一区二区| 色女人视频播放平台| 欧美色图一区二区三区水帘洞| 色窝窝视频在线播放| 国产成人精品一区二区三免费| 欧美矮马配女人无码下载| 秦先生在线亚洲欧美一区二区| 电子一区在线观看欧美| 色狠狠综合噜一二三区| 国产亚洲美国一区二区三区 | 国产A级无码色情软件免费下载| 欧美成人秘一区二区| 欧美茄子精品一区二区| 男女免费做暖暖视频| 色婷婷综合和线在线| 欧美熟妇精品黑人巨大一二三区| 精品成人一区二区三区四区| 青青草app成人看片软件| 国产亚洲欧美在线专区| 男人的天堂国产在线视频| 美女黄网站观看免费永久| 香蕉一区二区三区大区| 黄色地址欧美一区二区三区| 亚洲字幕中文在线字幕免费观看| 欧美成人精品一区二级V| 欧美老年性爱一区二区| 满18成人网站在线观看| 电影一区中文字幕| 国产伦精品一区二区三区最新版本更新时间| 欧美性猛交一区二区三区精品技师| 豆花视频一区二区三区| 麻豆一区二区三区西瓜视频| 国产亚洲成人综合aV| 欧美一区二区一级片视频| 欧美强奸乱伦一区二区| 污污污十大免费网站| 秋霞成人官网最新版本| 精品丝袜无码一区二区三APP| 美女隐私网站在线观看代码| 青青草视频TV成人版| 欧美精品系列一区二区| 欧美激情一区二区三区同女同性……| 色图馒头逼亚洲一区| 青青草app黄色视频下载| 欧美黄色录像一区二区三区| 黄色二A级成人网站下载| 亚洲性爱录像天美传媒| 美国一区二区毛片其地| 欧美黑丝一区二区三区| 国产一二线品福利区| 波多影视一区二区三区三区| 色偷偷欧美一区二区三区| 韩国一区二区在线视频| 自由色XXⅩ业余自由视频网下载| 欧美日韩精品一二区| 色综合最新地址是多少| 欧美日韩国产一区二区三区| 欧美成人色情一区二区三区| 国产99成人精品视频免费福利| 国产欧美一区二区色老头| 欧美网v6v2565.xyz| 精品免费产品日亚韩二三区| 男人把我添到了高潮A片软件| 欧美在线亚洲社区一区| 精品一区二区蜜桃免费| 国产成人手机视频网站| 欧美日韩国产免费一区二区三区四区| 欧美日韩激情一区二区| 男生射精的视频网站| 欧美视频中文字幕一区二区| 色老头影院一区二区| 欧美的一区2区三区| 美亚在线一区二区三区| 蜜桃二区三欧美一区二区mo| 欧美白人极品一区二区三区| 能免费看的国外最大的成人网站 | 翔田千里浓密一区二区三区四区| 亚洲成人一区、二区| 欧美强奸乱伦一区二区| 国产欧美精品一区二区三区四 | 色哟哟在线视频观看| 欧美成人一区=日区| 欧美推特一区二区三区| 欧美肏逼一区二区三区| 精品美女一区二区三区四区| 麻豆传媒一区二区三区天美传媒中文字幕| 欧美日韩精品十五区| 欧美视频一区二区| 欧美日韩成人水蜜桃| 男男自慰18禁网站| 精品一区三区三区半夜| 苹果午夜激情福利视频| 欧一美一婬一伦一区二区三区黑人| 男同十八禁网站入口| 蒂亚在线一区二区三区| 麻豆明星换脸一区二区| 本田岬人妻在线一区二区| 欧美日二区二区三区| 精品欧美黑人一区二区三区| 殴美野战一区二区视频| 色婷婷在线视频小树林| 黄网2025最新在线观看| 黑人巨大欧美精品一巨二区| 蜜桃麻豆一区二区视频在线| 精品人妻无码一区二区粉嫩| 欧美一区二区三区含羞草| 黄色.comsjfh| 黄色成人网站大全纯净版| 蜜桃传媒一区二区亚| 销售勾频网站在线观看| 精品欧美一区二区三区四区五区六区 | 特黄特色大片视频免费播放软件 | 欧美综合伊人一区二区三区四区 | 欧美色图成人网一区二区| 熟女亂伦一区二区三区| 欧美一区二区三区四区五区六区七匹| 男人女人裸体,免费下载| 欧美成人三区二区一区| 麻豆秘视频一区二| 综合社区亚洲欧美| 欧美波霸ol一区二区| 欧美精品一区二区三区三区视频| 欧美一区二区三区免费看| 亚洲成人一区二区不卡| 欧美搞操一区二区三区| 欧美日韩综合一区二区| 麻豆一卡区二卡三卡四卡区| 麻豆视传媒短视频最新网址入口| 欧美操逼视频一区二区三区| 国产成人手机视频网站| 欧美精區免费精區一区| 国产欧美一区二区三区免费 | 熟女人妻一区二区三区免费看 | 国产成+人综合+亚洲专区| 色图馒头穴亚洲一区| 欧美激情一区二区精品| 国产一区二区福利视频在线| 色丁香五月欧美综合| 欧美福利区一区二区文字| 美女自慰色网下载APP| 欧美视频一区二区App下载| 国产欧美黄乱绿一区二区三区| 欧美换妻一区二区三区| 黄色片子AV网站下载| 精品欧美一二区三区| 亚洲天堂成人在线社区| 蜜桃成人免费黄色网址| 欧美波霸ol一区二区| 国产亚洲综合第一区| 精东传媒视频高清观看免费| 欧美在线精品一区二区三| 锕锕锕锕锕锕锕锕锕锕好| 网站你懂我的意思吧| 欧美性爱免费之一区二区三区四区| 极品欧美一区二区三区四区五码| 男女成人app免费观看| 欧美一区二区三区男女性| 网红主播日韩一区| 亚洲成在人线综合导航下载全集免费| 重口老太一区二区三区免费| 看电影来5566中文版| 欧美一区二区三区夜夜| 亚洲天堂精品一区二区| 综合avtt天堂导航| 欧美大鸡吧一区二区| 韩国一二三区自拍偷拍导航| 欧美一区二区三区-黄色| 美国一级黄片一区二区| 欧美国产日韩一区二区三区粉嫩 | 色窝窝一区二区三区影视| 欧美日本宅男激情一区| 色悠悠一區二區三区| 欧美日韩精品一区二区三区四区五区 | 亚洲成年人在线观看| 色色色色色色色亚洲一区| 欧美插逼一区二区三区| 色窝窝一区二区三区成人| 欧美性爱区一区二区三区| 色婷婷亚洲成人网站| 亚洲成色在线综合网| 综合图区亚洲一区一本| 亚洲成人AV人兽综合社区| 精品一曲二曲三曲四| 国产成人综合亚洲看片| 鲁丝袜一区二区三区| 欧美最大免费视频一区二区| 视频一区视频二区欧美性爱| 极品销魂一区二区三区| 欧美爱爱一区二区二| 野花香社区色狼视频| 欧美性爱一区二区-百度| 美日韩一区二区三区四区五区六区手机免费| 老头天堂黄色视频网站| 欧美成人a62v免费视频| 美女18禁免费看视频APP| 欧美一区二区三区三线观看下载| 欧美色吧专区另类欧美色吧专区| 黄网2025最新在线观看| 欧美淫妇一区二区三区| 欧美婷婷丁香五月社区| 欧美精品一区二区潮喷| 视频一区++啊++啊++啊++啊+啊啊啊| 视频一区视频二区欧美| 欧美天堂性爱一区二区三区| 精品丝袜无码一区二区三APP| 国产精品成人aaaa网站女吊丝| 国产一二三App下载| 欧美成人一区二区直挂| 色狠狠综合一区二区| 欧美日帮一区二区三区频| 美女很黄网站是免费| 国产成人精品一区二区| 高速上的黄色情网战| 欧美日成人-区二区电影| 综合图区亚洲一区一本| 黄产国区一区二区三| 亚洲成人网址app大全| 欧美重口味一区二区三区| 风间由美一区二区三区四区五区| 亚洲成人综合第一页| 欧美黄色片网站下载 | 色久优优欧美色久优优| 国产欧美一区二区精品仙草咪平台介绍 | 欧美性爱区一区二区三区| 国产海角社区在线观看| 欧美日韩香蕉一区二区| 男人天堂网2025| 见见甘露妣妣阴蒂鲍鱼大香蕉一线天五月天久久香蕉精品香蕉精品 | 欧美一区2区三区4区公司| 欧美系列一区二区三区| 美女被操APP下载| 风间由美一区二区三区四区五区| 网红一区水蜜桃视频号| 麻豆传媒映画一区二区| 欧美一区二区h视频在线观看| 欧美精品一区二区三区黄瓜| 粉色午夜视频-SEBO98| 谁有午夜小视频网站| 国产成人综合亚洲亚洲欧美| 亚洲成人激情1区2区| 男人图片BBB| 色哟哟免费观看网站| 欧美一区二区三区狠狠干豆花 | 欧美淫妇一区二区三区| 国产精品人妻无码一区二区三区下载 | 国产一区二区福利片| 亚洲成人小说网站20245免费不要钱在线观看下载 | 黄总金莲一区二三区| 粉嫩阿拉伯一区二区三区| 视频一区中文字幕欧洲| 国产嫖妓一区二区三区按摩| 亚洲无码中文字幕在线免费观看软件| 欧美视频一区二区三区aaa| 精品不卡一区二区高速| 色色色色色色色亚洲一区| 麻豆国产传媒一区二区 | 香蕉久久AV绯色一二三四区| 国产欧美成人精品第二区| 亚洲成人app在线观看| 欧美日韩免费不卡一区| 黄总金莲一区二三区| 国产剧情一区二区西装正装| 欧美女神三级一区二区三级一| 非洲成人一区二区三区| 麻豆视传媒短视频网站安卓入口| 国产精品文轩探花一区二区| 亚洲无码成人app| 欧美性感一区二区三区| 欧美精品一区二区三区嫩模 | 西瓜浏览器二区三区| 黄色网址在哪里可以看?| 亚洲成人AV在线APP下载| 能免费看的国外最大的成人网站 | 枫富爱Av一区二区三区中文字幕| 欧美一区=区下栽入囗| 欧美一区二区三区最新网址| 欧美情色一区二区沤| 色老板一区二区三区| 青青草色情成人官网| 韩国爆乳内射免费一区二区| 黄网视频网站永久免费观看| 麻豆视传媒网站免费入口| 国产伦精品一区二区三区下载 | 黄色欧美视频一区二区| 国产成人AV又粗又大果冻传媒| 美女黄18岁免费下载| 美女露乳头100%无遮挡| 色老头在线视频免费观看亚洲| 韩国一区二区三区二区| 欧美成人精品一二区| 欧美日本宅男激情一区| 欧美成人踪合中文字幕| 欧美日韩一区二区三区不卡 | 欧美成人精品一区二区三区免费| 欧美日韩骑乘上位一区二区| 欧美独立站免费二区_欧美独立站免| 欧美精品一区二区中文无码| 欧美日韩一区二区日韩亚洲| 欧美成人精品二区三区| 欧美国产欧美一区二区| 亚洲成人一区二区不卡| 欧美v亚洲v一区二区| 欧美色图片一区二区| 韩国亚洲中午字母在线| 英美馒头逼不卡一区二区视频| 蜜桃视频网站18+| 能免费看的国外最大的成人网站 | 福利街区一区二区三区| 爱视频一区二区三区| 欧美综合亚洲综合欧美综合 | 桃花岛一区二区三区| 欧美福利片一区二区| 欧美婷婷丁香五月社区| 亚洲成人小说在线一区 | 国产享享色一区二区三区| 校花扒开腿让我C视频| 豆花视频一区二区三区| 网站你懂我的意思吧在线观看下载 | 国产嫖妓一区二区三区按摩| 黄片下载午夜免费观看| 视频一区视频二区欧美人妻| 黃色成人大片色大师下载免费| 视频号一区二区视频| 精品水蜜桃久久久久久久| 国产在线不卡二区精品一区| 香蕉变态搞鸡私密久久精品| 蜜乳一区二区三区中文字幕| 精品一曲二曲三曲四| 精品一卡2卡三卡4卡乱码破解版| 蜜月a∨精品一区二区三区| 迷情校园都市激情亚洲一区二区| 欧美精品性爱二区三区| 欧美新欢电影一二区| 亚洲天堂日本精品无码一区二区| 激情韩国一区二区三区| 欧美日韩国内一区二区| 亚洲天堂香蕉伊人卡一码| 桃子福利一区二区三区| 苹果午夜激情福利视频| 特黄特色大片免费播放器下载播放黄色大片。 | 青青草APP污污污| 国产精品一区二区综合| 视频区中文字幕亚洲欧美一区二区 | 金瓶梅一区二区免费| 男生下体网站免费观看| 欧美日本不卡三区一区| 国产日韩丝袜二区欧美| 欧美媱片一区二区三区| 国产一区二区三区四区五区蜜| 蜜桃臀专区一区二区| 激情综合网亚洲一区| 欧美性爱网站在线免费下载| 2025av无码91| 色狠狠综合一区二区| 欧美视频一区欧美视频二区| 亚洲成人网站免费观| 黄色香蕉网站黄色新闻| 精品秘一区二三区胖子| 欧美日韩人人精品牛牛影视| 国产成人兼职视频在线播放 | 亚洲成人综合一区二区| 杰克一区二区三区在线观看| 色婷婷一月在线视频| 欧美黑人一区二区三区久久| 亚洲成年人一区二区| 海角社区免费在线观看。| 亚洲成人网站第一区| 锕锕锕锕锕WWW湿透了视频| 激情国际一区二区三区 | 欧美日本韩国一二区视频| 欧0000XXXX| 美国大香蕉福利一区二区| 欧美玲传媒亚洲精品在线一区二区三区 | 青青久久99久久久久| 欧美高清片区1区2区3区| 亚洲无码高清下载| 蜜桃亚洲一区二区三区| 欧美综合精品一区二区高跟鞋 | 欧美小视频一区二区| 韩国羞羞漫画视频网站| 涩婷婷成人电影观看| 2025亚洲中文字幕在线| 美利坚合众国华人观看一区二区| 欧美精品一区二区三| 欧美性爱成人-区二区 | 欧美一区二区三区爱爱| 趁人网站亚洲中文| 欧美精品一区二区三区插入| 国产成人秘在线播放| 欧美一区二区三区深喉| 老少亂伦一区二区三区| 欧美操逼电影一区二区| 欧美综合一区,二区视频| 国产JJIZZ一区二区三区老人 | 黄色应用亚洲专区一区二区三区| 男人天堂2025手机在线免费观看| 亚洲成人网在线不卡性| 色婷婷成人做爰A片免费看网站正常男生是翻出来还是包着我高一躺着拍的大吗 | 国产欧美一区二区三区特黄手机版| 老熟女伦一区二区三区| 蜜桃一二三四五区视频| 特别色的看片软件快播在线观看| 亚洲成人日韩在线视频| 欧美在线精品一区二| 色婷婷婷手机免费在线视频| 红桃在线一区二区三区| 亚洲成人性爱一区二区| 美脚恋足亚洲精品一区| 欧美在线一二三四五区| 色帝国欧美在线二区| 欧美日韩一区二区福利| 国产伦一区二区三区免费| 本网站亚洲一区二区 | 老司机在线一区二区 | 欧美成人偷拍一区二区三区| 欧美成人精品一区二级V| 蜜桃精品一区二区三区欧美一区三区 | 2025亚洲人成人在线| 熟女露脸一区二区三区| 犬香蕉一区二区三区| 国产戓欧美一区二区| 黑巨人一区二区三区| 欧美校园另类一区二区| 蜜桃国际一区二区观看| 亚洲无码APP下载| 老司机成人视频盒子| 欧美性感视频区一区二| 翔田千里久久一区二区| 欧美日韩卡一卡二在线播放视频 | 亚洲影视欧美一区二区| 骚女人影院四虎影音| 欧美日韩一区二区日韩亚洲欧美 | 欧美精品电影一区二区| 青青草原女主播直播一区二区| 欧美洲激情国产一区二区在| 香港欧美一区二区三区四区在线下载| 欧美成人电影1区2区| 美国一区二区三区四区在钱视频| 欧美一区二区三区四区五区 | 欧美vr一区二区三区| 浴室里强摁做开腿呻吟免费看| 欧美视频一区二区| 青青视频在线观看免费高清视频下载| 欧美精品一区二区三区插入| 色花堂98一区二区三区| 亚洲成人在线观看app| 污污污免费网站嗯嗯啊啊| 亚洲成人在线点播影院| 邻居大乳人妻一区二区| 欧美大码一二区免费| 特黄特色大片手机在线观看| 欧美美女性爱一区二区| 色婷婷成人网站在线观看| 国产日韩粉嫩一区二区| 香蕉一级婬片A片久久精| 欧美影院亚洲精品一区二区| 销魂顶级极品一区二区| 亚洲成人社区1区2区| 深夜福利一区,二,区,三区。| 非洲成人一区二区三区| 欧美国产精品一区二区| 欧美黑人色一区二区| 色色网站免费下载双飞| 国产亚洲一区=区三区| 欧美日本一区二区在线| 男男被爽到翻白眼_| 欧美福利主播不卡一区二区| 红桃蜜桃视频在线一区二区| 黑人成人无码一二三区| 欧美熟女综合一区二区| 麻豆app入口网址| 欧美精品综合一区二区| 欧美一区,二区,三区视频播放| 欧美色图15p亚洲一区| 综合亚洲欧美亚一区| 欧美精品一区二区男人看| 精品垆土一区二区三区| 遂宁珠宝销售亚洲人成在线观看| 欧美一区二区三区中文子幕| 欧美激情综合一区二区| 特美1级aa免费。| 色乱码一区二区三区唱戏 | 精品一区2区三区中文| 黄色二A级成人网站下载| 欧美一区二区三区三线观看下载| 欧美日韩精品一区二区三区钱 | 野花社区AwwwAV| 国产一线二线三线成人网站| 欧美性交农村一区二区| 黄网站app免费大全中国| 亚洲成人一品成人一品| 页面访问升级新域名亚洲欧美一区| 国产欧美视频不卡一区二区| 欧美大奶一区二区三区| 欧美激情视频在线一区| 污黄啪啪网18以下勿进| 美女网站18BeautyWebsite18 | 欧美成人精品一区二区男| 欧美特黄一区二区三区| 网站一区二区肛欧美| 欧美色色三级综合一区| 秦先生在线亚洲欧美一区二区三区| 香蕉久久久久久久久久女人天堂一品 | 美女黄色18无下载| 锕锕锕锕锕锕锕好大| 黄片免费视频软件下载| 欧美成人精品一区二区| 韩国日本一卡二卡3卡4卡网站| 欧美一三区在线不卡| 欧美性激情一区二区| 欧美激情性视频一区二区| 欧美精品成人一区二区直挂| 深夜精品福利一区二区| 熟女俱乐部一区二区| 精品久久久久中文字幕| 老司机福利appios| 老牛嫩草二区三区观影体验| 野花香社区论坛视频| 韩国乱码卡一卡二新区网站| 黑人干白人三级一区二区| 欧美高清视频一区二区三区| 狠狠撸亚洲一区二区三区| 欧美一区二区三区另类| 亚洲天堂黄色三级网站2021| 欧美在线观看一二区| 欧美日另类一区二区| 欧美成色手机在线综合| 欧美激情一区二区三区成人百度| 欧美网站区二区三区| 欧美现场观看一区二| 欧美精品AⅤ一区二区三区| 欧美视频免费观看一区二区三区| 深夜福利一区二区| 国产成人综合电影专区| 黄色国产一区二区三区| 香蕉变态搞鸡私密久久精品| 香蕉久久一区二区三区| 韩国成人一区二区三区| 里番精品3D一二三区| 蜜桃一区久久久久| 黄片下载一区二区三区| 黑人巨大精品欧美一区二区免费| 欧美黄色一区二区色色色| 欧美精品一级二级三级四级五区六区| 欧美色影AⅤ一区二区| 欧美激情一区二区视频| 欧美日本宅男激情一区| 欧美大香伊一区二区三区| 亚洲成人日韩在线视频| 欧美一区二区三区啪啪啪| 欧美激情第一区二区三区| 欧美日韩在线观看一区二区三区在线观看App下载 | 欧美成人18一区二区| 欧美大橡胶色中色一区二区三区| 亚洲成人第一在线大区| 国产精品欧美分区| 2023国产精品一区二区三区| 国产AV1区二区三区| 韩国三级一区二区三区| 欧美精品一区、二区、三区| 欧美激情一区二区三区高清视频 | 欧美家庭成人一区二区| 欧美在线亚洲app| 欧美日本成人电影一区| 色色资源免费服务平台欧美性爱三区 | 国产二区高清在线观看| 骚女骚穴欧美一区二区| 色情欧美人妻一区二区| 欧美一区二区三区交流| 麻豆文化传媒官网最新| 老头添女荫道口视频免费| 粉嫩一区二区三区免费| 欧美美女一区,二区,三区| 欧美成人一二三区一| 欧美日逼网一区二区| 美国一区二区免费视频| 欧美视频免费观看一区二区三区| 欧美成人视频不卡四区| 国产日韩丝袜二区欧美| 国产手机亚州欧美在线| 蜜乳一区二区三区中文字幕| 精品一区二区三区欧美人妖| 欧美色色三级综合一区| 欧美在线精品一区二区三| 国产福利资源在线观看| 非洲一区二区三区免费| 美国一区二区三区四区在钱视频 | 欧美v亚洲v日本| 高清1区2区3区4区产品| 综合网婷婷成人综合网| 欧美精品动漫一区二区三区| 亚洲成人男子天堂一区二区| 国产一线二线三线资源| 色老头国内精品视频免费| 激情丁香婷婷五月网| 欧美成人精品一区二区三区艳母| 欧美一区日韩一区| 豆花视频一区二区三区| 私人成人亚洲一区二区| 欧美日韩福利一区二区| 国产欧美一区二区精品性| 欧美性爱一区三区三区| 黄色免费app欧美| 美女露乳头100%无遮挡| 粉嫩性色一区二区三区AV下载 | 激情欧美一区二区免费视频 | 国产成人淫淫淫一二三区| 颤抖小蜜桃成人网站| 国产精品久久久久久苹果| 色欲综合一区二区三区| 波霸国产一区二区三区| 亚洲无码在线成人色黄app下载 | 欧美一区二区三区后| 长篇亚洲欧美一区经典| 激情对白欧美蜜桃欧美一区二区三区| 欧美日本成人电影一区| 永久黄区观看在线网址| 亚洲成人AV在线APP下载| 国产欧美国产欧美一区二区| 美女隐私网站免费看| 欧美熟妇精品一区二区蜜桃视频| 欧美一区不卡绿帽子| 欧美大香伊一区二区三区| 麻豆传媒视频一二三区| 涩婷婷成人电影观看| 亚洲女人天堂2025| 欧美性丝袜一区二区| 精品一区欧美激情| 欧美国产精品一区二区| 超频在线青青草视频| 欧美色图15p亚洲一区| 男人天堂网2025| 亚洲成人无码福利一区| 谁有午夜小视频网站| 精品午夜福利无人区乱码一区| 麻豆app入口网址| 国产精品一区二区综合亚洲| 欧美高清…一区二区三区| 欧美激情视频一区二区三区福利| 欧美一区二区在线播放| 欧美日本一区二区在线观看| 欧美性猛交一区二区三区精品技师| 欧美精品一区二区三区的| 亚洲撸啊撸国产欧美一区二区| 欧美性生交XXXXXBBBBB| 欧美一区二区三区二区| 麻豆精产国品一二三产品何苗| 色优优333444| 欧美一区二区三区不卡黄片| 特黄特色大片免费观看播放器 | 粉色视频成人网站入口| 欧美精品在一区二区| 欧美影视一区=区三区| 国产成+人+综合+欧美亚洲| 欧美韩精品一区二区三区网站下载 | 欧美精品无码一区二区三区19| 亚洲成人播放器视频亚洲色| 精品无人妻一区二区| 欧美一区二区三区少妇调教| 黑人巨大精品欧美一区二区免费| 色窝窝线视频在线观看| 美国一级片黄色下裁| 湖南一区二区三区网站| 亚洲天堂诱惑夜福利| 国产一区二区视频福利| 国产V欧美综合一区二区三区 | 精品一区二区三四区| 深夜福利精品一区二区三区| 色欲APP在线观看| 2025亚洲天堂无码视频手机版| 国产成人短视频一区二区三区| 福利一区二区欧美| 欧美激情一区二区三区成人百度 | 骚逼情骚逼一区情侣二区| 永久免费观看的黄网站| 欧美射精暴插精品一二区、| 色八戒国产一区二区三区| 亚洲成年精品一区.| 精品一区二区久久蜜桃| 皮皮精品一区2区三区| 欧美yazhou区综合| 涩涩网站在线免费下载| 亚洲成人爱情动作片一区二区| 香蕉视频在线观看视频色老头| 激情戏欧美一区二区三区老人| 国产水手服19禁视频| 红桃在线一区二区三区四区| 欧美一区二区三区性爱| 淫荡乱伦欧美一区二区| 黄页网站大全在线免费观看 | 福利视频一区二区刺激| 黑人成人无码一二三区| 欧美成人无码一二三区| 真人无码国产性教育片mp4| 页面访问升级一区二区| 欧美一二三四五六区| 欧美极品东京下载| 永久m3u8成人网站| 黄桃视频一区二区三区四区| 欧美国精产品一二区| 欧美韩国一区二区三区| 色欲综合一区二区三区| 欧美一区二区三区四五六七八| 欧美韩国日本一区二区| 欧美无人区二区三区| 亚洲无码不卡大桥未久| 欧美黄片一区二区3区| 色丁香五月欧美综合| 国产伦精品一区二区三区妓女下载安装| 欧美激情一区二区视屏蜜桃| 祝自己不快乐生日文案| 韩国乱码一区二区三区| 2025国产精品久久久| 欧美成人AAA一区二区| 涩涩视频网站app下载| 色图馒头穴亚洲一区| 杰克一区二区三区在线观看| 亚洲无码转旷2025| 欧美激情视频一区二区在线观看| 欧美一区二区三区整片| 视频一区无码破解| 极品私人玩物欧美一区亚洲| 亚洲手机热产中文无码| 欧美波霸ol一区二区| 国产成人在线播放视频| 青苹果一区二区三区| 国产欧美一区二区三区hd| 亚洲无码在线成人色黄app下载 | 亚洲成动漫一二区蜜桃 | 阿姨一区二区三区四区| 国产AV1区二区三区| 欧美一区二区三区白人| 欧美深喉吞精一区二区视频| 涩色网站.com6391| 男生露jiji网站| 精品欧美一线二线三线蜜桃| 韩国在线一区二区三区| 本田岬人妻在线一区二区| 特黄特色特爽免费视频| 综合avtt天堂导航| 老司机大香蕉午夜福利| 韩国欧美三区四区小视频| 国产又爽又黄免费| 国产欧美精品一区二区三区 | 欧美女同激情一区二区| 涩涩撸亚洲精品综合| 爆日45岁沈阳熟女| 精品垆土一区二区三区| 色哟哟一网二网三网| 青青草社区在线APP下载| 国产一区二区三区欧洲| 国产成人手机视频网站| 国产精品欧美分区| 真人做爰到高潮18禁网站| 精品欧美一区二区成人| 老司机黄色成人app视频| 蜜桃精品一区二区三区91视频 | 蜜桃综合在线一区b| 琪琪伦理yy6080| 精品国际一区二区三区欧美| 色婷婷成人做爰A片免费看网站 | 欧美理论在线一区二区情侣| 欧美精品在线免费下载| 求一个app软件看毛片?| 国产真人做爰45分钟| 欧美一区二区三区的性| 亚洲成人精品一区店| 欧美大黄一级片免费的| 欧美成人女同一区二区I| 欧美性猛交一区二区三区精品| 欧美激情性视频一区二区| 欧美精品一区二区三区日区| 欧美首页一区二区三区| 污污网站视频观看大全免费 | 美国一区二区免费大黄片| 精彩亚洲一区二区三区四区| 网站动漫你懂我意思吧app| 美国一区二区三区AV| 欧美一区二区三区公司| 国产欧美一区二区三区特黄手机版| 国产福利视频一区二区| 精品一曲二曲三曲四曲五曲区| 美女黄18岁免费下载| 欧美一区二区三区爽一级鸡巴草逼| 亚洲成人播放器视频亚洲色| 欧美好看视频一区二区| 欧美一区二区三区极品| 国产福利精品一区二| 黑人精品一区二区三区不一卡| 欧美老妇精品一区...| 欧美激情成人一区二区| 欧美成人福利一区二区三区| 亚洲成人网一区不卡| 国产精品一区二区欧美| 黄色电影18wwwwwwwwwwwwwwwwwwwwwwwwwwwwwwwwwwwwwwwwwwwwwwwwwwwwwwwwwww | 欧美日韩亚洲韩国一区二区 | 色欲av火龙果一区二区| 美女的隐私部位网站| 精中文区一区一区三区| 水野朝阳精品一区二区| 欧美第一区在线视频| 欧美成人一区二区精品下载| 亚洲成人欧美一区二区| 熟女人妻乱一区二区三区视频| 欧美视频一区二区三区欧美性xxxx极品高清3d | 色窝窝一区二区三区四区五区| 色哟哟导航视频在线观看| 精品人妻午夜一区二| 淫岳肥妻一区二区三区| 欧美日韩国产群交派对| 欧美大屁股熟妇一区二区| 欧美一区,二区,三区的男人们| 国产精品一区二区亚洲| 黄色欧美一区二区三区四区| 裸美XXX一区二区三区| 精品欧美激情二区三区| 老阿姨一区二区三区| 熟女论坛女人社区一区| 欧美福利社区一区二区三区| 欧美成人一区二区成人免费| 欧美成人精品一区二级V| 欧美日本一区二区在线播放| 欧美大肥逼一区二区| 国产成人无码网站m3U8| 2025亚洲日韩欧美在线免费观看黄片 | 黑丝无毛骚逼一区二区| 色yoyo在线一区| 牛牛精品传媒一区三区wwww| 欧美第一区在线视频| 欧美一区二区三区的性| 黄色a毛网站免费下载| 色接久久720p下载| 黄色地址欧美一区二区三区| 色成人网站在线免费抖音ww| 熟富婆一区二区三区啪啪TV| 蜜桃v天堂一区二区| 精品一二区三区四区| 欧美独立站成人一区二区| 美国精品一区二区三区| 欧美视频一区免费看| 亚洲日本AⅤ精品一区二区| 国产成人+综合亚洲+偷拍| 色窝窝一区二区三区成人| 男人的天堂国产在线视频| 欧美精品一区二区三区三区视频 | 欧美在钱一区二区三区| 国产伦一区二区三区四区| 色呦呦视频在线观看| 爱草莓第一福利导航| 亚洲无码不卡一区二三区| 麻豆文化传媒免费下载入口| 综合久久字幕久久本道久久| 欧美激情一区二区三区中文字幕| 欧美一区二区三区啪啪高清 | 色哟哟导航视频在线观看| 欧美黄色片网站下载| 亚洲成色在线综合网站| 高HH写真视频网站免费看| 污黄啪啪网18以下勿进| 亚洲日本AⅤ精品一区二区| 欧美激情爆操骚逼精品区| 国产成人无码性教育sm| 精品美女一区二区三区四区| 欧美激情一区二区平| 黄网站大全在线下载| 美女黄色18无下载| 欧美女王一区二区三区| 欧美老狼人一区二区三区| 2025成人在线看| 亚洲成人资源综合网| 欧美一区二区三区狠狠干豆花| 亚洲成人在线免费福利| 欧美成人三区二区一区| 视频区图片区小说区综合色区| 欧美高清在线一区二区三区四区 | 色区直播区色欧美区 | 国产在线不卡卡卡不卡卡卡| 美女少妇无遮挡网站在线观看视频下载| 欧美视频网站一区二区三区| 国产欧美一区二区m| 亚洲成人第一网站免费| 菠萝蜜一区二免费进免费| 欧美视频一区在线观看| 国产成+人+综合+欧美亚洲| 福利盒子手机看片一区| 欧美澈情另类一区二区三区| 黄色网一区二区三区| 水蜜桃一区二免1688| 欧美一区,二区,三区成人祝频| 老牛视频传媒精品一区| 欧美日韩精品一区二区香蕉下载| 亚洲无线网一区欧美日产| 国产欧美成人精品第二区| 精品一区二区三区三州小圈| 美女妹子无圣光一区二| 欧美激情一区二区三区p站| 欧美精品黑人一区二区三区 | 亚洲日本不卡一区二区| 色婷婷丁香五月丁香| 欧美性感一区二区三区| 色yeyeyeye| 音影先锋久久资源网站| 精品欧美激情二区三区| 欧美床上拍一拍一二区| 美女18.com| 欧美一区二区三区网站-标清迅雷1080 | 精品亚洲欧美成人一区二区| 欧美一区二区三区四区五区无卡码| 精品熟人一区二区三区四区| 美国一区二区在线播放| 欧美一区二区三区俄罗斯肥妇| 红桃蜜桃视频在线一区二区| 欧美一区二区三区少妇p| 网红主播福利一区在线观看| 亚洲成人一区、二区| 红豆视频一区二区三区| 亚洲成人无码一区二区| 综合一区二区三区欧美| 欧美一区二区三区含羞草| 神木丽一区二区三区四区五区| 欧美一区二区三bbbb| 电影《恋童》完整版在线观看| 国产精品一区二区午夜福利| 欧美综合一区二区三区四区| 鲁丝袜一区二区三区| 欧美成人电影院免费色婷婷老司机| 谁有午夜小视频网站| 欧美把胖子激情一区| 网站大家懂我意思吧免费| 国产欧美日韩一区二区妖精| 欧美一区二区| 欧美成人性生活,一区二区| 色哟哟网站在线观看| 欧美video一区二区| 欧美黄片一区二区三区| 韩国一区二区三区二区| 欧美孕妇一区二区三区| 熟富婆一区二区三区啪啪TV | 精品人伦一区二区三区四区下载| 男人天堂网手机在线观看| 韩日中文字幕合集下载| 欧美大香蕉伊思一区二区| 狠狠色婷婷成人色情综合网| 亚洲成人直播一区二区| 欧美日韩精品一区二区香蕉下载| 欧美精品一区二区jsjdhfhdjsk| 精品免费产品日亚韩二区精品| 欧美激情做爱一二区| 熟妇高潮精品一区二区三区下载 | 香蕉狼人一区二区三| 美女扒开腿:秘:免费网站| 欧美一区=区下栽入囗| 欧美成人无码一二三区| 美国一区二区美国一区二区√| 欧美色吧专区另类欧美色吧专区| 国产欧美一区二区精品性色超碰| 精品一区二区三区蜜桃免费按摩| 亚洲成人在线点播影院| 国产成人兼职视频在线播放 | 亚洲成人网在线观看| 色欲亚洲精品一区二区| 2023国产一二三区日本精品2025| 欧美香蕉视频播放一区| 色老头在线视频福利| 欧美熟妇一区二区三区四区 | 欧美成人精品一区二区三区毛片| 红豆视频一区二区三区| 黄片app入口观看免费| 欧美性一曲二曲三曲| 浴室里强摁做开腿呻吟软软件 | 湖南一区二区三区网站| 色窝窝一区二区三区四区五区| 欧美一区二区三区在线观看免费| 欧美色色三级综合一区| 精品国产欧美一区二区三区不卡| 黄avapp网站| 欧美性爱在线一区二区| 波多手机在线一区二区| 欧美成人影视一区二区三区| 漂亮的人妻一区二区| 色五月一区二区三区春桃一影视| 色八戒一区二区三区四区五区| 国产成+人+综合+欧美亚洲| 欧美一区二区三区导航| 欧美一区二区三区AA| 沈樵外卖一区二区三区免费观看电视| 红日,欧美,国产,亚洲精品。| 欧美煌瑟网站久久一区下载| 欧美在线一二三四区| 欧美日韩一区二区污| 欧美日韩国产区二区三区| 欧美日韩亚洲一区二区美腿| 欧美性生活一区二区三区| 欧美性爱一区二区激情| 欧美大胆视频一区二区| 亚洲成人一线二线| 欧美一区二区三区四区视频 | 欧美一区二区三区水牛影视| 亚洲无砖砖区2021免费| 欧美极品美女一区二区三区| 欧美精品一区二区三区三区 | 欧美成人小视频一区| 欧美自慰无码一区二区下载| 欧美老妇人XXXX一区二区三区| 欧美观看免费欧洲二区| 欧美爱爱爱一区二区三区| 欧美成人aa视频下载| 亚洲成人精品一区二| 国产成人在线tube| 国产91对白播放边| 国产伦一区二区三区四区| 蜜芽TV-miya188.mon| 麻豆传媒午夜福利神马影院| 精品欧美一区二区三区四区五区六区八区九区十区 | 蜜桃传媒一区二区亚洲AV| 欧美成人一区二免费| 国产123区m3u8| 欧美熟妇一区二区高清| 麻花豆剧国产mv免费| 欧美在线一区二区三区视频| 色婷婷成人在线观看直播| 亚洲无卡精品一区二区三区| 欧美成人精品一区二区综合| 骚女人影院四虎影音| 色久优优欧美色久优优| 亚洲日本AⅤ精品一区二区| 野花社区www日本官网| 欧美成人A片在线免费看| 欧0000XXXX| 欧美成人女同一区二区I| 美国一区二区毛片其地| 欧美日韩精品一区二区三区四区免费| 高清1区2区3区4区产品| 欧美成人精品一区二区三区视频下载| 色狠狠综合一区二区| 亚洲日本天堂入口第一| 亚洲无码中文字幕在线免费观看软件| 色色网站免费下载双飞| 亚洲成人黄色电影一区二区| 男同十八禁网站入口| 香蕉久久国产Av一区二区| 欧美成人乱码一二三四区免费| 美国大香蕉福利一区二区| 黄总金莲一区二三区| 欧美精品一区二区三区三区| 色色色色色色色色色色欧美三区| 欧美成人女同一区二区I| 欧美色图片一区二区| 美女18网站app| 国产一区二区三区一个人| 欧美狠狠噜日一区二区| 神木丽av无码专区观看| 韩国伦理一区二区不卡| 欧美女神三级一区二区三级| 激情欧美一区二区三区| 色狠狠综合一区二区| 麻豆国产传媒一区二区| 亚洲性爱欧美天堂一区二区| 欧美激情一区二区三区高清视频| 福利姬视频一区二区| 美脚恋足亚洲精品一区| 蜜桃久久一区二区三区| 铃木心春一区二区三区| 麻豆直播一区二区三区| 樱桃视频一区二区三区| 国产欧美一区二区精品仙草咪平台介绍 | 亚洲日本国产不卡一区 | 美国成人视频一区二区| 麻豆实验室一区二区精品蜜桃免费看| 欧美性爱一级片一区二区三区| 片多多一区二区三区| 美国一区二区三区视频| 苍井空AV字幕无码| 精品福利自慰一区二区三区| 色窝窝一区二区无码| 香蕉久热一区二区三区| 桃色成人在线亚洲一区| 国产成人综合亚洲亚洲欧美| 欧美日韩网红明星一区二区三区| 国产成+人欧美+综合在线观看| 欧美精品一区二区亚洲蜜臀| 污视频app下载大全| 欧美精品二区三区四区免费看视频| 色情欧美人妻一区二区下载视频| 2025年最新mv免费入口| 国产福利片二区| 麻斗app官方下载| 色老头av网站合集| 粉嫩av一区二区三区天美传媒| 真人无码国产性教育片mp4| 浴室里强摁做开腿呻吟免费看 | 特级欧美婬片免费高清| 欧美一区二区三区凹凸视频| 熟妇偷情一区二区三区| 欧一区二区二区二区二号二号码包| 国产一区二区欧美日韩| 欧美一区三区五区八区| 黄色网址哪里可以看| 2025国产成人精品| 美女扒开尿口露出奶头直播app| 色呦呦视频seyouyou| 欧美成人一级_亚洲国精产品| 永久免费AV无码网站直播| 亚洲天堂视频网苹果| 真人做爰片免费视频毛片中文| 男人的天堂手机版在线观看| 欲色aV一区二区三区天美传媒| 欧美日韩精品一区二区三区四区免费| 国产精品人妻无码久久久郑州天气网| 黄色二级成人网站下载| 欧美综合伊人久久一区二区三区四区| 欧美淫荡一区二区三区四区五区| 精品一二区三区四区| 欧美精品一区二区福利视频| 牛牛精品一区二区中文字幕| 欧美视频在线观看免费一区| 欧美激情网一区二区| 国产精品人妻无码免费下载 | 麻豆视传媒短视频网站| 真人性爱视频APP下载大全| 欧美影视精品一区二区| 麻豆一二三产区密桃| 老牛嫩草二区三区观影体验| 欧美一二三区性交做爱| 亚洲成人在线观看app| 欧美调教视频一区二区| 神马午夜色色福利电影院| 韩国一区二区三区中文字幕| 欧美色图15p亚洲一区| 欧美视频一区二区三区四区五区| 欧美视频自拍一区| 国产精品午夜成人AAAAA| 欧美特黄aaaaa一区二区| 欧美日本一区二区视频| 点播美国的a带a带a带| 欧美黑丝制服在线日韩| 熟女做爰一区二区三区| 欧美手机在线一区二区| 老司机在线一区二区| 黄片下载午夜免费观看| 黄色大香蕉APP网站| 精品国产欧美一区二区三区不卡| 欧美一区二区三区88| 欧美好看视频一区二区| 综合欧洲色情三区七区| 欧美破处一区二区三区| 精品秘一区二三区免费雷安胖子| 色窝窝高潮一区二区| 韩国欧美一区二区三区| 黄网视频网站永久免费观看| 2025在线国产视频| 欧美一区二区三区的性| 色婷婷在线观看视频网站| 香蕉av久久一区二区三区| 麻豆传文化传媒网站入口免费| 欧美日韩人成综合黄色| 正在播播不卡的一区二区| 欧美精品一区二区唯美| 韩国一区二区三区视频| 欧美清晰一区二区三区| 国产99成人精品视频免费福利| 老熟妇欧美高潮一区二区三区| 莉娜保罗一区二区三区| 欧美一区二区三区水牛视频| 黄页网站在线观看大全免费 | 国产成人亚洲综合色之色| 非州精品一区二区三区| 深夜福利一区二区| 欧美一区二区三区网址| 国产J8又粗又大又爽又长| 欧美精品一区二区地狱猫| 男人露jiji秘免费网站暗夜 | 欧美日本一区二区免费| 欧美成人小视频一区| 欧美一区二区三区免费视频播放器| 亚洲天堂色吧一区二区三区| 欧美性生交XXXXX无码公司| 欧美一区二区三区熟女| 精品久久久久中文字幕| 美洲天堂一区二卡三卡四卡 | 精品一卡二卡三卡中国app | 海角社区在线视频免费观看| 亚洲天堂福利视频一区...| 亚洲成人看片一区二| 欧美一区二区三区精美影视| 韩国专区一区二区eidi| 福利社区一区二区三区四区五区| 欧美毛卡片一区二区| 麻豆视传媒短视频网站 | 欧美精品久久久久夜夜久久久| 欧美短视频精品二区| 亚洲成年人一区二区| 骚女人影院四虎影音| 苏妲己户外一区二区三区| 美国精品一区二区三区| 欧美整片一区二区三区| 麻豆二区三四五六七八区区| 欧美一区二区三区后| 欧美精品免费一区二区三区| 欧美视频一区免费看| 韩国专线福一区二区| 欧美性爱网站在线免费下载| 涩婷婷成人电影观看| 欧美网站区二区三区| 欧美搞逼一区二区三区| 国产伦精品一区二区三区最新版本更新时间| 亚洲性夜色噜噜网站| 欧美一区二区三区四区五区在干嘛呢?| 本一区二区三区中文字幕| 亚洲天堂精品一区二区| 亚洲成人一区二区| 亚洲成人av一区二区| 欧美激情一区二区A片成人牛牛| 美女色网站可下载一区| 色窝窝无码一区二区三区| 糖心一区二区久久久| 国产探花一区二区三区四区| 国产一区二区亚洲精品| 粉嫩一区二区三区四区五区| 毛片qq群2025| 男女中文亚洲日韩| 综合网婷婷成人综合网| 精品人妻一区二区三区微信 | 殴美一区二区三区不卡| 熟女露脸一区二区三区| 精品人妻无码一区二区三区葡京| 欧美一区二区三区综合色| 亚洲天天精品综合一区| 欧美日韩精品一区二区三区四区五区| 毛卡一卡二卡三免费| 欧美日韩直播视频在线播放二区| 黄色网址哪里可以看| 超碰香蕉一区二区三区| 渴望茱莉亚-性色av色香蕉一区二区三区-成人AV| 欧美精品一区二区三区涩爱蜜| 亚洲成人小说网站2024免费不要钱在线观看下载 | 国产欧美一区二区三区鸳鸯幕| 亚洲无矿专区2025| 国产精品手机一区二区| 男人的大ji巴视频| 国产福利电影一区二区| 男男shibajin| 欧美成人精品一区二区三区毛片| 男女激情海外一区二区在线观看| 色窝窝精品无码一区二区三区| 毛片qq群2025| 韩国欧美日本一区二区三区| 国产亚洲一区=区三区| 国产成+人+亚洲+欧美综合,| 欧美成这样人一区二区| 欧美婷婷一区二区三区| 欧美性爱视频一二区| 欧美性爱一,二,三区| 国产欧美精品一区二区色综合朱莉| 视频在线亚洲一苹果| 国产欧美综合一区二区三区| 粉色视频成人网站入口| 色哟哟成人免费短视频| 国产一区二区午夜福利| 欧美大码一区二区免费| 黄桃视频一区二区三区四区| 色窝窝无码一区二区三区色色7| 欧美精品无码不卡一区二区三区 | 海角天涯社区在线播放免费在线看| 男生露jiji秘网站免费| 老寡妇日韩一区二区三区| 精品熟人一区二区三区| 欧美福利视频一区二区三区四区| 欧美一区二区三区免费看教程 | 精品美女一区二区三区四区| 欧美成人电影院免费色婷婷老司机 | 涩淫亚洲欧美一区二区| 污污污视频网站在线观看下载| 熟女人妻视频一区二区| 粉色影院精品一区二区欧美激情 | 欧美特级黄色一级网络| 欧美香蕉一区二区三区| 红桃蜜桃视频在线一区二区| 国产又爽又黄视频安装| 熟女円城ひとみ爱色AV| 精品一区,精品二区入口下载| 色欲综合欧美一区二区三区| 亚洲无码不卡大桥未久| 精品一曲二曲三曲四| 亚洲成人涩涩一区二区| 香蕉精品资源一区二区三区| 真人做爰片免费毛片中文 | 欧美综合一区二区三区| 真人做爱45分钟视频| 精品一区二区三区四五区| 欧美成综合在线观看| 国产日本欧洲亚洲一区| 精品人妻无码一区二区三区葡京| 国产成人直播视频在线播放| 国产成人深夜福利不卡一区| 国产精品不卡一区二区三区| 特黄一区二区三区三州| 欧美色图亚洲色图一区二区| 黄金币色精品一区二区| 红日,欧美,国产,亚洲精品。| 香蕉久热一区二区三区| 青青草app成人看片软件| 欧美黄色国产一区二区| 香港欧美一区二区三区四区资源下载| 色窝窝免费视频在线观看| 欧美成人视频肥逼一区二区| 欧美日韩人成综合黄色| 欧美ph一区二区三区在线| 国产精品成人AAAAA网站| 网站一区二区三区四区五区6区2025| 色呦呦免费观看视频| 欧美情色一区二区沤| 末广纯在线一区二区三区| 欧美国产激情一区三区| 综合社区亚洲欧美| 色图馒头穴亚洲一区| 美国观看一区二区在线| 欧美激情啪啪啪一区二区三区| 韩国美女自摸一区二区三区| 精品欧美一区二区成人| 欧美成人aa视频下载| 美国黄色视频一区二区三区| 海角天涯社区在线播放免费在线看| 欧美日韩一区二区日韩亚洲| 神木丽无码一二三区在线观看| 欧美牲交a欧美牲交aⅴ免费下载| 麻花传媒剧国产MV在线观看| 欧美福利社区一区二区三区| 疯狂的肥岳一区二区三区| 欧美一区二二区在线观看| 男人的天堂一区二区三区四区五区六区七区 | 浴室里强摁做开腿呻吟的更新时间| 美女扒开尿口露出奶头直播app| 蜜月a∨精品一区二区三区| 香蕉久久aⅴ一区二区三区| 给我一个人最新色情网站| 男人天堂网2025| 2025国内精品久久久精免费| 男生舒服网站在线观看破解版| 国产一区欧美一区i| 欧美一区二区三区按摩在线| 片多多一区二区三区| 欧美激情欧美狂野一区| 欧美性爱一区二区三区| 欧美精品一区二区无码| 非洲一区二区三区摸| 波多影视一区二区三区三区| 亚洲成动漫一二区蜜桃| 香蕉久久国产AV一区二区| 欧美独立站免费二区_欧美独立站免 | 国产亚洲综合第一区| 黄网永久app免费在线观看| 男女性裸体网站在线下载视频| 欧美激情一区21P| 亚洲成人AV苹果影视| 国产成人综合在线视频App| 色呦呦在线观看网站| 黄片App下载污欧美| 海角社区在线免费观看视频| 欧美日本一区二区免费| 颤抖小蜜桃成人网站| 欧美一区二区三区红| 深夜福利一区二区| 清纯唯美五月丁香婷婷综合 | 精品欧美黑人一区二区三区 | 青青草视频免费下载| 蜜桃'一区二区在线观看| 红豆视频一区二区三区| 色小孩影院欧美一区| 欧美综合激情一区二区| 欧美激情一区二区的| 黄页网站大全在线免费观看| 麻豆精产国品一二三产品何苗| 欧美视频啪啪啪一区二区| 国产一区二区成人撸视界| 国产成+人+亚洲+欧美| 欧美色综合一二三区| 黄色omeiaaa1| 色开心色五月丁香综合| 欧美成人另类一区二区| 页面访问升级亚洲一区| 欧美一区二区三区成人片下载| 国产成人综合在线视频App| 欧美一区二区三区精东视频视| 黄网浏览器在线观看视频| 男男做爰猛烈高潮在线观看| 欧美一区二区三区四区五区在干嘛呢? | 欧美巨茎精品一区二区三区| 色哟哟免费观看网站| 欧美一区二区三区婷婷| 欧美综合伊人一区二区三区四区 | 欧美成人综合一区二区| 精品日韩二区三区精品视频 | 欧美字幕一二三四五区| 国产一区二区欧美一区| 色八戒一区二区三区| 麻豆传媒一区在线天堂岛| 欧美精品一区二区三区爽爽爽黑白配| 香蕉app成人版下载| 破解日韩一区二区| 污黄啪啪网18以下勿进| 精品一区,二区,三区,四区装逼。嗯哼。| 欧美激情一区二区视频免费下载观看| 国产成人免费视频ViP| 蜜桃精品一区二区不卡| 理伦一区三区美国亚洲| 蜜桃AV成人永久免费| 美女姐姐隐私视频网站| 亚洲成人黄片一区二区三区| 欧美一区二区三区免费入口 | 欧美色图图片一区二区| 欧美一区二区三区白丝| 精品欧美一区二区精品少妇| 范冰冰精品一区二区| 欧美日韩区一区二区| 色哟哟――免费专区| 亚洲成人福利导航社区| 男女啪啪做爰高潮全过软件| 国产成人欧美成人在线观看| 色窝窝视频在线播放| 色婷婷成人网站在线观看| 2025国产久视频| 欧美天堂性生活一二三四区| 欧美一区二区三区不卡| 欧美一区二区三区激情无套| 欧美一区,二区,三区成人祝频 | 熟女人妻乱一区二区三区视频| 色窝窝无码精品一区二区三区| 欧美熟女一区二区不卡| 欧美德国双飞淫二区| 风流老俗女一区二区| 精品日韩二区三区精品视频| 欧美性生交XXXXX无码公司| 亚洲射精品午夜射精韩日| 激情对白欧美蜜桃欧美一区二区三区| 海角社区免费在线观看。| 色情欧美人妻一区二区下载视频| 精品一区二区三区三州小圈 | 极品露脸一区二蜜桃| 国产欧美精品一二三四区| 欧美福利社区一区二区三区| 精品社区一区二区三区黑料| 欧美成人精品一二区| 欧美一区二区三区成人视频| 国产一线二线三线女装品牌| 欧美福利一区二区| 蜜芽-mytv188| 国产福利一区二区视频| 香蕉AV一区二区三区| 色八戒一区二区三区四区五区 | 欧美少妇一区二区三区| 蜜桃视频网站18+| 香蕉久久夜色2023| 国产成人+综合亚5| 鲁丝一区鲁丝二区鲁丝三区αv| 欧美老女孩子激情三区| 永久免费欧美一区二区| 男生射精免费观看网站| 综合一区欧美一区| 激情东京一区二区三区| 欧美黑人好粗一区二区| 欧美激情视频一区二区三区福利| 韩国专区一区二区eidi| 欧美屄p一区二区三区四区| 国产精品亚欧美一区二区| 欧美精品一区三区四区| 欧美熟妇高潮一区二区 | 欧美黄片一区二区3区| 精品卡一卡二卡3卡高清乱码| 欧美激情一区二区三区四区五区| 欧美一区亚洲精品| 老头添女萌道口视频| 真人做爰片免费毛片中文| 美女全黄免费看网站| 精品一二区三区四区| 亚洲字幕欧美色不卡一区二区三区 | 亚洲成人一线二线| 激情久久一区三区二区| 欧美日韩欧美黄色一区二区| 欧美多人片高潮野外做片黑人| 蜜桃成人网站导航| 欧美激情爆操骚逼精品区| 色欲AV一区二区| 美国黑人大屌一区二区| 狠狠干一区二区三区| 黄色.comwww| 福利街区一区二区三区| 色情网站免费大全入口| 综合久久加综合久久| 福利亚洲10000| 欧美一区二区三区哚哚| 国产一区二区三区成人| 欧美澈情另类一区二区三区| 欧美精品一区二区三区黄瓜| 欧美成人性色生活一区二区| 欧美日韩一区二区综合| 欧美高清视频一区二区三区| 韩国一区二区视频免费| 欧美视频播放二区三区。一区长还 | 欧美一区不卡绿帽子| 欧美老熟妇50,60,70,80一区二区三区| 极品露脸一区二蜜桃| 清纯唯美亚洲欧美中文一区三区四区| 消息称老熟妇乱视频一区二区| 精品垆土一区二区三区| 欧美巨茎精品一区二区三区| 欧美激情一区二区三区公司| 欧美np啊啊啊啊一区| 秦先生在线亚洲欧美一区二区三区| 污视频app下载大全| 国产欧美日韩精久一区二区 | 麻豆传媒一区二区三区| 麻豆动漫人口免费下载| 欧美整片一区二区三区| 精品一卡二卡三卡中国app | 麻豆国产传媒一区二区| 欧美老熟妇50,60,70,80一区二区三区 | 美女视频在线观看网站APP| 粉嫩精品一区二区三区| 欧美精品系列一区二区| 男人天堂2025手机在线免费观看| 苹果视频一区二区| 福利广场爱视频一区二区| 国产中文区二暮2025| 欧美曰韩综合一区二区三区| 欧美日韩中文字幕| 国产无圣光福利一区| 色窝窝无码一区二区| 国产福利一区二区三区漫画| 国产一线二线三线在线无码| 色婷婷免费情趣视频| 欧美成人乱码一区二区三区| 黑木奈美无码未删版| 黑人精品欧美一区二区蜜| 欧美射精暴插精品一二区、| 欧美日韩一道本在线播放| 神木丽无码一二三区在线观看| 色窝窝一区二区三区| 欧美一区二区三区成践| 国产欧美日韩精品一区二区三区| 精产国品一区二区色大师| 欧美一区二区三区HD| 欧美独立网站第一区| 国产一区二区欧美精品| 国产成+人+综合+欧美亚洲| 爆乳hitomi亚洲一区二区| 香蕉成人视频网站下载| 国产成人精品一区二区三免费| 欧美色网一区二区三区| 欧美爽爽爽一区二区| 香蕉蜜桃一区二区三区| 欧美成人激情图片视频一区二区| 精品人妻无码一区二区三区四川人 | 美脚恋足亚洲精品一区| 美国黄色高清一区二区三区| 亚洲天堂网站红桃| 欧美综合一区,二区视频| 欧美一区二区三区三页| 黑丝一区二区三区,| 亚洲成人网站2023免费不要钱在线观看下载 | 欧美日韩一区二区三区四区 | 欧美一区三区免费成人| 美女隐私部位的网站| 色欲网址App下载| 亚洲成色www.com| 麻豆视传媒短视频网站安卓入口 | 欧美精品久久久久久久免费软件| 欧美成人线路一线路二| 永久免费欧美一区二区| 爱草莓第一福利导航| 麻逗传媒文化一区二区| 激情床吻一区二区免费| 麻斗传媒官方官方网站| 国产欧美一区二区三区特黄手机版 | 欧美成人精品一区二区三区艳母 | 欧美淫妇一区二区三区| 国产精品一区二区欧美| 欧美激情视频一区二区三区| 谷露影院熟妇人妻一区二区| 欧美一区二区三区夜夜嗨| 黑人成人无码一二三区| 高清一区二区三区四区区| 欧美日韩一区二区三区不卡| 韩国专线一区二三区| 香蕉网站一区二区,三区| 2021亚洲卡一卡二新区| 海天翼中文字幕一区二区三区| 2025年的久久精品| 麻豆转煤官方网站入口| 苹果国产成人视频| 黄片α片在线免费观看| 欧美成人怡红院一区| 精品社区一区二区三区黑料| 欧美永久激情一区二区| 国产欧美日产一区二区三区人妖 | 苹果成人网在线观看| 美国一区二区欧美亚洲| 欧美性激情一区二区| 欧美激情一区=区三区| 黄网站大全在线下载| 欧美视频在线一区二| 高中生一区二区三区视频| 国产成人精品一区二区| 国产欧美日韩一区二区妖精| 综合久久,综合色蜜桃| 萌白酱粉色jk一区二区| 国产成人综合美国十次| 欧美日朝国产一二三四区| 黄色视频污污软件老司机| 网站欧美XXXXX| 精品欧美一区二区三区四区五区 | 美国成人精品一区二区| 色窝窝无码一区二区三区AV| 精品免费一区二区三区四区| 色情视频软件在线免费观看 | 污污网站视频观看大全免费 | 欧美成人无码一区二区三区| 热门导航一区二区推荐| 激情A片久久久久久app下载| 粉嫩一区二区三区四区| 韩国演艺圈卡一卡二新区| 欧美日韩国产综合一区二区| 欧美福利视频一区二区| 黄网站在线观看下载| 欧一美一婬一伦一区| 水蜜桃传媒一区二区| 欧美激情欧美精品一区二区三区 | 韩国一区二区三区中文字幕| 国产欧美成人综合免费| 深夜福利一区,二,区,三区。| 海角社区免费在线观看。| 蜜桃臀久久久蜜桃臀久久久蜜一区二| 国产成人淫淫淫一二三区| 白白发布免费在线播放视频| 男人露jiji秘免费网站推特| 美欧日一区二区三区四区| 苹果午夜激情福利视频| 欧美日韩一区二区三区撸大师| 欧美日本一区二区红桃| 欧美美女一区二区三区成人美一区| 黄片App下载污欧美| 美女很黄网站是免费| 欧美精品一区二区少| 亚洲成色在线熟女人| 欧美激情一区二区三区亚洲视频声音太大| 欧美精品一品二品二品二品| 韩日一区二区三区四区| 精品一区二中文字幕| 蜜芽TV-miya188.mon| 国产中文区二暮2025| 美国精品无码一区三区| 黄色小说成人电影在线免下载| 欧美精品一区二区地狱猫| 深夜精品福利一区二区| 2025国产成人精品一区| 神木丽在线一区二区| 国产乱码卡一卡二新区网站| 欧美日逼网一区二区| 国产一区二区精品下载在线观看| 精品亚洲欧美成人一区二区| 欧美性大片一区二区免| 欧美日韩国产精品一区二区三区四区五区| 欧美成人免费下载免费| 黑人巨大精品一区二区三区兔费 | 精品无码久久久久成人漫画| 美国一区二区三区精品视频| 香蕉成人一区二区一起cao| 欧美成人秘一区二区| 美国观看一区二区在线| 欧美日韩一区二区日韩亚洲| 色婷婷丁香五月综合婷婷| 欧美一区二区三区视频| 精品无码人妻一区二区免白雪公主| 欧美精品电影一区二区| 欧美自在线一区二区| 亚洲成人AAASA| 网站你懂我的意思吗免费| 欧美色图图片专区一区二区三区传媒 | 金品一区视频怎么下载| 欧美淫荡一区二区三区四区五区| 欧美激情爆操骚逼精品区| 激情久久一区三区二区| 韩国gogogo高清在线完整版| 国产品精1区2区三| 福利社区一区二区三区四区五区| 欧美强坚一区二区三区| 欧美性爱精品一区二区| 欧美成人在线一区二| 欧美色图之精品一区| 欧美成人精品一区字幕| 欧美精品黑丝管一区二区三区| 欧一美一婬一伦一区| 福利视频神马影院午夜福利| 欧美极品白浆一区二区| 欧美成人在线成人一区| 欧美视频一=三区‘| 视频在线一区二区欧美博 | 欧美极品东京下载| 美国一区二区线观看| 欧美日韩精品一区二区三区钱| 欧美成人免费一区二| 牛牛影视无码一区二区| 美女推油一区二区三区| 片多多一区二区三区| 欧美福利片一区二区| 欧美色/23我>2| 欧美日韩精品一区到四区| 欧美视频一区二区| 2025一区二区国产免费| 色噜噜狠狠一区二区三区牛牛影视 | 国产又爽又黄视频安装| 苍井空无码中文字幕| 色www免费下载视频网站| 鲁丝一区二区三区免费| 亚洲成人aaa1区二区| 欧美牲交a欧美牲交aⅴ免费下载| 精品媚药一区二区三区四区| 色情.m3u8网站| 欧美波霸影视一区二区| 欧美性爱综合一区二区三区| 欧美精品一区二区婷婷| 欧美精品秘一区二区三区蜜| 白富美性爱一区二区| 禁精品一区二区三区三州府| 欧美精品一区二区色多多香蕉 | 糖心一区二区久久久| 欧美私人+一区二区| 深夜在利视频最污平台| 国产又爽又黄A片免费观看| 神马不卡一区二区三区| 欧美调教论坛一区二区| 欧美成人乱码一二三四区免费| 欧美留学生一区二区在线视频| 殴亚日韩一区二区三区| 男女欧美视频一区二区三区| 国产福利视频一区二区在线观看| 涩婷婷成人电影观看| 亚洲妓女一区二区三区| 精品一区,精品二区入口下载| 鲁大师日本一区二区| 网站黄在线观看免费| 男女搞黄网站在线观看| 欧美一区二区三区操| 亚洲成人精品一区二区| 熟女女优导航一区二区三区| 欧美一区二区三区另类视频| 欧美成人色一区二区三区凹凸| 欧美一区二区三区精美影视| 欧美一区二区一级片视频| 欧美日韩福利一区二区| 欧美黄色短视频一区二区三区四区一色天 | 欧美成人精品A片免费看一区| 男人的大ji巴视频| 粉嫩欧美一区二区三区| 鲁大师无码人妻一区| 欧美视频VIDEO一区二区| 极品美女网红一区二区| 老少亂伦一区二区三区| 爱视频一区二区三区| 欧美日韩不卡一区二区去 | 色窝窝手机在线观看| 亚洲成人综合激情网| 欧美女性爱一区二区三区| 蜜桃综合在线一区b| 欧美黄性视频一区二区三区| 亚洲天堂无码一区二区| 欧美在线观看不卡一区二区视频 | 精品欧美一区二区三区四区| 欧美一区二区三区男女一级视频 | 阿姨一区二区三区四区| 黑人巨大精品欧美一区二区三区| 欧美日韩黄色电影下载| 欧美日韩一区二区三区撸大师 | 亚洲影院一区二区欧美| 麻豆传媒在线一级二级| 欧美一区二区高清视频| 欧美成人一区二区男同| 国产一区二区欧美三区| 麻豆视传媒适当放松| 亚洲女人黄色视频APP下载网站| 韩国专区福利一区二区| 欧美一区二区三区俄罗斯肥妇| 海角社区视频在线观看| 老头天堂黄色视频网站| 欧美日韩亚洲台湾一区二区| 闩日本成人亚洲一区二区| 2025成人在线看| 亚洲天堂色情天堂一区| 欧美日韩123区不卡| 网站懂我意思吧视频在线观看| 欧美老太不卡乱交一区二区三区 | 色婷婷图片视频成人福利| 欧美一区二区三区四区视频| 亚洲成人网址app大全| 麻豆传媒视频一区!| 白白色发布免费视频| 欧美一区二区三区网站-标清迅雷1080| 男男十八禁网站免费| 麻豆天美一区二区免费视频| 欧美真人视频一区二区| 粉嫩黄牛一区二区三区| 老司机三分钟免费体验区| 2021亚洲砖码专区| 深入无人区短剧免费高清观看| 综合杏色影视丁香五月婷婷| 黄网站大全在线下载| 男生私密照免费下载网址 | 欧美毛卡片一区二区| 深夜福利精品一区二区三区| 欧一欧二欧三免费观看| 欧美日韩精品一区二区三区四区免费 | 激情东京一区二区三区| 特级欧美婬片免费高清| 欧美精品一区二区福利视频| 亚洲宗合另类色日韩| 欧美韩国日本一区二区| 香蕉精品二区二区三区四区五区| 欧美成人h一区二区| 欧美一区二区三区四区五区六区七区八区 | 色哟哟不卡免费视频| 国产精品一区二区看黄| 欧美成人精品二区免费| 国产乱码卡一卡二新区网站| 香蕉视频美国三区二区一区| 黄色一级片日本一区二区| 超乳爆乳一区二区_亚| 色天下一区二区三区| 国产J8又粗又硬又大| 越南妓女一区二区三区| 欧美高清视频三区四区| 综合亚洲中文在线一区| 国产欧美一区二区三区视频明星换脸 | 欧美非洲一区二区视频| 真人做爰免费视频看| 污污视频免费看萝莉白丝袜子小红书 | 男人天堂国产视频综合网| 野花香日本大全免费观看| 精品欧美一区二区三区四区五区六区 | 欧美精品一区二区潮喷| 欧美按摩一区二区三区| 美国美女在线一区二区| 精品欧美区一区二区三区四区| 蜜桃臀网免费无码视频| 欧美一区二区三区交流| 狠狠色成人欧美一区二区三区| 魅影亚洲一区二区| 闩日本成人亚洲一区二区| 欧美成人精品一区二区αⅤ| 黑人精品欧美一区二区蜜| 殴美野战一区二区视频| 国产一区二区苹果视频| 欧美插插一区二区| 麻豆文化传媒公司导航| 欧美激情办公室一区二区| 欧美破处一区二区三区| 国产精品文轩探花一区二区| 欧美巨茎精品一区二区三区视频| 亚洲手机在线一线二线三线| 欧美激情一区二区三区不卡视频| 神木丽无码START-326| 美国粗屌免费一区二区| 精品媚药一区二区三区四区| 黄网视频网站永久免费观看| 视频一区视频二区欧美性爱| 男女做暖暖一区二区三区| 美欧日一区二区三区四区| 国产精品手机一区二区| 欧一区二区免费在线观看| 色窝窝视频在线播放| 法国精品精品一区二区| 欧美成人小说一区二区三区| 激情对白欧美蜜桃欧美一区二区三区| 欧美性一曲二曲三曲| 黄色片成人网站免费| 青青草视频TV成人版| 牛牛影院一二三区精品视频| 国产福利一区二区三区漫画| 激情床吻一区二区免费| 窝窝熟女超碰一区二区| 亚洲无码不卡一区二三区| 国产精品成人aaaa网站女吊丝 | 国产一区二区欧美日韩| 男人天堂网在线观看| 欧美综合区自拍亚洲综合绿| 欧美操逼一区二区三| 欧美护士区一区二区| 国产成人欧美一区二区三区的| 欧美一区二区三区在线看哚哚影院| 精品欧美一二区三区| 欧美男性射精高潮视频网站 | 牛牛影院一区二区三区| 美国一你大黄片一区二区三区| 欧美一区二区三区在线观看免费 | 麻豆传媒免费版2025| 男人天堂网干干干干| 欧美巨茎精品一区二区三区视频| 欧美日韩中文一区二区三区四区 | 2025年成人网站| 翔田千里珍藏版无码| 亚洲成人福利导航社区| 麻豆视传媒app官方在线看| 欧美精品一区二区三区三州| 香蕉黄色色欲网站App| 色成人网站在线免费抖音ww| 精品欧美一区二区成人| 欧美黄色做爱成人一区二区| 黄网站大全安免费黄在线| 欧美成人69SSS| 欧美女人视频下载大全免费| 黑人AV一区二区三区| 欧美一区二区三区爽一级鸡巴草逼| 欧美成人淫秽破处一区二区| 污污污视频网站在线观看下载| 麻豆传媒在线一级二级| 欧美黑人一区二区三区久久| 欧美爽歪歪一区二区三区| 欧美一区二区三区四区五区午夜福利 | 杨晨晨ThetrnAV一区二区三区| 欧美精品一区二区三区一品| 欧美成人性色生活一区二区| 精选欧美一区二区视频| 香蕉免费日本一区二区三区| 鲁丝片一区二区三区四川人| 欧美精品电影一区二区| 亚洲成人色网址导航美国| 黄师傅AV一区二区| 麻豆app入口网址| 美日欧中一二三区高清| 欧美成人一级_亚洲国精产品| 黄色片成人网站免费| 欧美。插.。.二区| 欧美成人一区二区无| 茄子视频A片一区二区| 青草视频www成人网站下载| 男同十八禁网站入口| 欧美精品在一区二区| 欧美一不卡二不卡三不卡| 韩国亚洲中午字母在线| 沈樵外卖一区二区三区免费观看电视 | 熟妇高潮精品一区二区三区下载| 欧美牲一区二区三区| 萌白酱一区二区三区| 肉丝和欧美激情一区二区| 色逼看的软件成人快手| 欧美一区,二区,三区成人祝频| 麻豆传媒av1区2区| 欧美粗大一区二区三区四区| 欧美一区二区三区四区五区六区七匹 | 欧美黄色片网站下载 | 熟女円城ひとみ爱色AV| 欧美日韩亚洲一区二区蜜| 欧美白人激情观看一区二区三区| 国产欧美区精品二区| 美国一区二区不卡免费| 视频一区二区精品中文字幕| 欧美美女一区二区视频| 亚洲影院一二三区澳洲| 老A影院亚洲一区二区| 黄色网址在线观看下载观| 精品人妻一区二区三区鲁大师| 秋霞成人官网最新版本| 欧美综合,一区,二区,| 欧美高清砖码一二区| 欧美一区二区三区成人视频| 欧美一区二区三区日本一区二区三区 | 国产一区二区三区成人| 熟妇高潮精品一区二区三区下载| 国产剧情一区二区西装正装| 石榴一区一区三区四区五区a'v| 欧美成人踪合中文字幕| 欧美精品一区二区三区四区合区| 欧美日韩香蕉一区二区| 欧美熟妇精品一区二区蜜桃 | 欧美一区二区三区在线精 | 欧美成人一区二区三区四区| 男人天堂日韩一区二区| 亚洲成人视频手机版| 欧美成人五区不卡免费| 欧美一二三四区免费观看| 青草视频www成人网站下载| 欧美激情电影不卡一二区| 色哟哟在线播放网站| 国产99成人精品视频免费福利| 精品秘无码一区二区三区老师苹果| 欧美日韩大陆一区二区| 欧美成人A片完整版免费看| 黄色欧美在线一区二区三区| 美女少妇无遮挡网站在线观看视频下载| 亚洲成人精品成人一区| 欧美精品一区二区三区14p| 欧美强坚一区二区三区| 国产一区二区三区成人| 欧美激情视频在线观看一区二区 | 亚洲性夜色噜噜噜在线| 国产成人免费视频ViP| 波霸院一区二区三区| 亚洲无码一区二区探花| 极品美女网红一区二区| 色婷婷成人免费视频网站| 国产欧美日韩综合精品一区二区 | 荷兰视频一区二区三区| 青苹果一区二区三区| 欧美一区二区三区成人木片| 色情网站免下载观看| 欧美色吧专区另类欧美色吧专区| 黄色APP在线观看一区二区三区 | 红桃蜜桃视频在线一区二区| 亚洲成人下载免费观看| 精品淫妻一区二区三区四区| 亚洲影院精品一区二区三区三州| 美女隐私网站直接免费观看| 艾娃亚当斯一区二区三区最新消息视 | 亚洲成人在线第一页| 麻豆产国品一二三产品在线| 国产伦精品一区二区三区妓女下载安装 | 欧美色影AⅤ一区二区| 欧美成人线路一线路二| 欧美日韩123区不卡| 亚洲无码中文日韩人妻2025 | 欧美激动一区二区三区| 欧美在线精品一区二区三区影院| 亚洲无码一区二区三区四区五区| 超碰香蕉一区二区三区| 老头添女荫道口视频免费| 色一色亚洲一区二区| 欧美成人乱码一区二区| 青青草app色版网站免费| 欧美一区,二区,三区的男人们 | 蜜桃色永久入口网站| 欧美一区二区三区另类视频| 蜜桃臀欧美精品一区二区| 欧美一区二区三区囮区| 综合亚洲中文在线一区| 男人露jiji秘自制视频| 麻豆视频网站app| 香蕉AV一区二区三区| 国产一区二区欧美丝袜| 欧美成人五区不卡免费| 美女隐私网站免费观看视频| 电影一区中文字幕| 亚洲少妇一区二区三区| 鲁丝一区鲁丝二区鲁丝三区αv| 茄子视频A片一区二区| 欧美xxxxx成人| 欧美一区二区三区四区在线| 国产成人十万一千五十六区在线播放| 蜜桃二区三欧美一区二区mo| 男男被爽到翻白眼网站| 蜜桃一二三四五区视频| 国产精品一区二区看黄| 老阿姨一区二区三区| 黄片下载午夜免费观看| 黄色一区二区三三区 | 色天使在线一区二区三区| 视频号一区二区视频| 欧美性爱爱一区二区三区| 麻豆产国品一二三产品区别| 激情欧美在线一区二区三区 | 水多多亚洲一区二区| 国产伦精品一区二区三区蜜月| 欧美色图片二区三区| 森川安娜一区二区三区| 国产欧美一区二区精品性| 黄涩欧美一区国产一区| 欧美色欧美亚洲另类二区 | 精中文区一区一区三区| 樱桃视频一区二区三区| 殴亚日韩一区二区三区| 让岳怀孕一区二区三区| 美腿御姐一区二区三区| 黄色成人网站大全纯净版| 国产日韩欧美二区三区| 欧美激情综合一区二区| 精品欧美一区二区蜜桃免费,91综合四虎 | 精品一区二区三区视频下载| 国产福利精品一区二区三区| 韩国三级一区二区三区| 精品区一区二区三四区香蕉| 青草视频www成人网站下载| 色yeye免费视频在钱| 神马不卡一区二区三区| 欧美激情一区二区三区中文字幕| 欧美熟女啪啪一区二区| 欧美国产精品一区二区在哪里买| 男人的天堂国产在线视频| 殴美区二区三区电影| 男女久久久久久久蜜桃| 欧美精美一区二区三区 | 欧美激情吞精一区二区| 精品欧美激情二区三区| 沈樵外卖一区二区三区免费观看电视 | 麻豆AB一区在线观看| 亚洲成人爱情动作片一区二区| 欧美激情一区21P| 国产精品成人AAAA网站女吊丝| 色窝窝精品无码一区二区三区| 美国一区二区在线播放| 亚洲愉拍一区二区三区| 糖心logo在线观看视频| 欧美熟女女优一区二区| 黄片下载午夜免费观看| 欧美综合精品良家一区二区| 男生免费露jiji| 欧美成人精品a一区二区| 棉花糖大奶-蜜桃视频| 欧美日另类一区二区| 殴美老太性生活一区二区 | 黄色成人网站大全纯净版| 超碰97成人无码中文字幕APP| 美亚在线一区二区三区| 欧美一区二区三区免费看教程| 欧美一区二区三区成人电影| 韩国爆乳内射免费一区二区| 欧美日韩激情一区综合| 麻豆传媒在线观看二区| 国产精品一区二区三区欧美一区 | 综合社区亚洲欧美| 欧美激动一区二区三区| 精品一区和精品二区| 欧美美女性爱一区二区| 精品伦精品一区二区三区| 迅雷下载一区二区| 美国美女在线一区二区| 能免费看的国外最大的成人网站| 狠狠干一区二区三区| 网红一区水蜜桃视频号| 欧美日韩一区二区粉嫩| 欧美视频一区免费看| 欧美一区二区三个区视频 | 欧美粗大一区二区三区四区| 国产精品一区免费下载| 麻豆传某官网app| 福利社区一区二区三区四区| 亚洲无码中文字幕在线免费观看软件 | 国产成人网红在线看| 香港,台湾高潮不卡,一区,二区,三区。| 雅虎日本免费一区二区| 福利导航永久地址App下载| 国产一区二区精品下载在线观看| 色妞***一区二区三区四区| 欧美一区二区三区三级影视| 欧美性爱一区二区社区| 欧美魅影一区二区三区| 西野工刂力欧美二区| 国产盗摄精品一区二区酒店| 青青草原一区二区三区四区蜜桃 | 黄网站永久免费在线| 国产精品AAAAA| 国产撸一撸一区二区| 超碰97成人无码中文字幕APP| 2025久久国产精品网址https://| 色凹凸香蕉一区二区| 黄色亚州一区二区三区| 美女18.com| 水多多日韩二区| 黄本子视频网站在线看| 欧美福利视频一区二区三区四区| 欧美图区一区另类图区一区丁香| 欧美精品一区二区跑去| 网址在线观看你懂我意思吧?| 水蜜桃实验麻豆一区| 腿扒开让我添69式m| 韩国乱码卡一卡二新区| 欧美手机版一级黄色性爱网站| 欧美成人69SSS| 老牛视频传媒精品一区| 福利导航永久地址App下载| 国产精品一区二三区三亚| 极品露脸一区二区蜜桃| 麻豆app入口网址| 欧美成人_区二区三区| 苹果内射dv一区二区| 韩国理论知识在线一区二区在线| 老阿姨一区二区三区| 欧美一区二区三区狠狠干| 翔田千里久久一区二区| 亚洲成人捆绑av网站| 求个网站你懂的2025| 麻豆视频网站app| 沈阳熟女露脸对白视频| 欧一欧二欧三免费观看| 涩色网站.com391| 麻豆转煤官方网站入口| 欧美日韩一区二区三区| 欧美一区二区三区卡卡| 麻豆传媒一二区网站| 欧美成人一二三区一| 韩國女主播精品一區二區| 网站动漫你懂我意思吧app| 苏妲己户外一区二区三区| 海角社区在线免费观看视频| 美亚在线一区二区三区| 欧美日韩国产一区二区| 欧美精品一区二区菲菲影视恶人 | 欧美精品一区二区菲菲影视恶人 | 欧美成人精品一区二区男| 韩国视频一区二区三区| 枫哥在线一区二区三区| 精品免费产品2023最新| 欧美狠狠噜日一区二区| 亚洲成人欧美一区| 欧美精品一区二区三区涩爱蜜| 欧美一区二区三区凹凸视频| 窝窝社区www成人版| 欧美激情一区二区三区不卡视频 | 色区直播区色欧美区 | 美女妹子无圣光一区二| 足疗店双飞女技师一区二区| 青青草视频App苹果下载| 色色哟免费观看王者| 香港,台湾高潮不卡,一区,二区,三区。 | 熟女人妻一区二区三区| 欧美激情一区蜜桃视频| 蜜桃久久成人一区二区| 美脚恋足亚洲精品一区| 殴美geeexx一二三区| 欧美字幕一二三四五区| 国产欧美日韩一区二区三区四区| 2025亚洲天堂无码视频手机版| 欧美一区二区三区伊人| 亚洲成人久久一线二线| 欧美在线不卡一区二区| 潮喷视频app下载| 精品福利三区囚区五区| 欧美性爱网一区二区| 精品一二区三区四区| 国产福利片一区二区| 美女网站黄永久免费观看| 国产日韩粉嫩一区二区| 男女久久久久久久蜜桃| 野花视频在线欧美二区三区| 欧美精品免费一二三区| 香蕉久久久久久久久久女人天堂一品 | 激情欧美一区二区蜜桃视频| 欧美视频一区二区| 亚洲无码APP下载| 黄师傅AV一区二区| 水蜜桃福利一区二区三区| 蜜桃传媒一区狼人综合干练| 国产欧美精品区一区| 欧美日韩国产综合一区二区 | 欧美成人网一区二区| 黄色二级成人网站下载| 欧美成人性生活,一区二区| 本日无久湾一在区道 | 精品人妻人妻人一区二区有限公司| 老妈日本老奶一区二区| 欧美成人精精品一区二区红桃| 欧美色图15p亚洲一区| 欧美精品一区二区色| 欧美成人精品一二区| 国产精品亚欧美一区二区| 欧美图区视频一区主播| 国产专区,亚洲一区| 欧美茄子精品一区二区| 海角社区成人激情在线观看| 欧美黑丝一区二区三区| 欧美精品成人一区二区三区四区 | 色窝窝无码一区二区三区四区 | 亚洲无矿专区2025| 蜜桃九九九一区二区| 香蕉水蜜桃一区二区三区| 美国成人视频一区二区| 国产一线二线三线成人网站| 茄子视频A片一区二区| 美女黄18下禁止可观看网站| 欧美黄色大片一区二区| 欧美综合一二三四五六| 香蕉淫秽视频一区二区三区| 特黄特色特爽免费视频| 国产成人兼职视频在线播放 | 国产日本欧美一区二区| 男男免费看,十八禁| 青青视频在线观看免费高清视频下载| 美国大香蕉一区二区| 韩国一区二区三区二区| 欧美激情乱伦一区二区三区| 精品欧美一区二区精品少妇 | 黄偏高在线免费观看| 极品私人玩物欧美一区亚洲| 欧美精英^Ⅴ一区二区三区四区五区六区| 水蜜桃福利一区二区三区| 黄页网站18以下勿看| 2025国产一区二区三区在线观看 | 海角社区免费视频播放| 麻豆传媒亚州一区二| 欧美精品一区二区免| 殴美成人五级黄色网| 国产天美娱乐一区二区| 欧美视频一区三区免费| 综合欧洲色情三区七区| 欧美激情一区二区三区公司| 欧美日本一区二区爽爽爽| 野花社区AwwwAV| 欧美一区二区高清视频| 美女黄网站免费看过| 欧美视频一区在线观看| 欧美最新视频一区二区| 色婷婷婷手机免费在线视频| 国产大神欧美一区二区| 韩日一区二区三区四区五区六区| 综合一区欧美一区| 肉丝和欧美激情一区二区| 麻豆传媒视频回家一区| 欧美一区二区三区公司| 超碰香蕉一区二区三区| 欧美风情中文字幕一区二区三区| 亚洲成人免费性情网站| 国产亚洲欧美另类一区| 欧美性爱二区三区四区| 深入无人区短剧免费高清观看 | 欧美一区二区三区性爱| 韩国成人一区二区三区| 美国一区三区二区视频| 渚光希一区二区三区| 亚洲成人一区二区| 欧美性爱制服诱惑一区二区| 亚洲性爱一区天美传媒| 欧美精品欧美一区二区三区| 黄污视频APP网站V| 色婷婷一月在线视频| 欧美宅男666一区二区| 亚洲成人2区在线| 欧美精品一区二区三区四区合区 | 欧美成人精品一区二区三区四区 | 麻豆网站官方免费进入| 爱尔兰性视频一二区| 欧美激情一区二区三区成人百度| 亚洲天堂成人在线社区| 青青草大香蕉亚洲欧洲一区二区| 熟女人气视频一区视频二区| 男人露jiji秘免费网站推特 | 老司机永久免费福利影院| 亚洲天堂最新免费视频| 窝窝社区www成人版| 欧美色欧美亚洲另类二区| 黄网站免费下载观看| 韩国一区二区视频免费| 国产精品一区二区看黄| 激情内射日本一区二区三区,| 男女差差差差差打扑克视频| 长篇亚洲欧美一区经典| 欧美一区二区三区四区五区六区七匹 | 香蕉久久免费不卡一区| 亚洲无码有限责任公司一区 | 欧美日韩黄色一区和二区| 白富美性爱一区二区| 麻豆星空传媒一区二区| 国产成人综合亚洲看片| 美女被黄18禁下载| 视频二区恢复在线看免费版| 男人的大ji巴视频| 欧美一区二区三区卡卡| 国产成人直播视频在线播放| 香蕉网站一区二区,三区| 风骚少妇精品一区二区三区四区| 欧美激情在线观看亚洲一区 | 亚洲成人AV苹果影视| 玖草在线免费资源站| 黄色应用亚洲专区一区二区三区| 老熟女熟妇一区二区三区| 香蕉app成人版下载| 欧美巨茎精品一区二区三区| 欧美成人精品一区二区三区免费 | 黄网站免费永久在线观看下载| 亚洲成人直播一区二区| 神马飘花一区二三区| 特黄特色大片免费视频app3g关闭窗口 | 国产一区二区午夜福利| 欧美特级制作一区二区| 网页升级访问日韩一区| 欧美日韩骑乘上位一区二区| 亚洲情侣自拍成人网| 麻豆视频适当放松一下| 亚洲成人久久一线二线| 亚洲成人综合在线一区| 男生露出jⅰj网站| 欧美日韩激情一区综合| 神马午夜福利一区二区| 蜜桃视频网站18+| 麻豆精产国品一二三区别软件| 精产国品一区二区三区免费| 2025成人地址你懂得| 欧美色欧美亚洲另类一区二区三区 | 国产欧美精品亚洲一区二区| 黃色A片一级一级一级久别的草原 黃色成人大片色大师下载免费 | 色偷情亚色-亚洲欧美精品一区二区 | 欧美都市激情一区二区三区| 熟女熟妇一区二区三区| 欧美大奶子艹逼一区二区三区| 欧美熟女一区二区三区| 欧美一区二区三区四区五区黄色| 欧美激情亚洲综合区| 国产熟女伦一区二区| 欧美成人淫色一区二区| 韩国一本道免费黄色| 色呦呦在线观看入口| 校花主动脱让我网站| 国产专区,亚洲一区| 熟女俱乐部一区二区| 亚洲成人一二三福利| 疯狂的肥岳一区二区三区| 欧美拳交在线视频一区| 欧美日韩亚洲韩国一区二区| 色婷婷网址最新在线| 菠萝菠萝蜜最新视频一区二区三区 | 蜜桃九九九九一二三区| 精品人伦一区二区三区闺蜜| 黄色软件一区二区在线观看| 老司机成人视频盒子| 国产精品口爆一区二区| 黄网站app免费大全中国| 欧美多阴毛女性视频一区二区| 国产海角社区视频在线看| 欧美独立网站第一区| 麻豆国产精品一二三区别软件| 欧美日韩国产群交派对| 色哟哟在线视频成人| 熟女老阿姨一区二区| 亚洲成人社区1区2区| 欧美一区二区三区下载| 欧美视频一=三区‘| 欧美肥逼狠狠爱一区二区| 黑人巨大精品欧美一区二区三区色欲 | 亚洲成人捆绑av网站| 欧美日韩最新一区二区| 黄产国区一区二区三| 国产网红在线欧美| 欧美情色一区二区三区四区五区| 麻豆传煤入口免费进入2023| 国产享享色一区二区三区| 国产精品一区二区综合亚洲| 美国精品一区二区三区四| 欧美一区二区三区性| 亚洲成人国产综合| 国产日本欧美一区二区| 香蕉精品二区二区三区四区五区| 亚洲成人资源综合网| 视频一视频二在线观看 | 美臀熟女一区二区三区| 福利在线一区二区三区| 青青草app色版网站| 欧美一区二区中文视频| 亚洲天堂日本社区网| 消息称老熟妇乱视频一区二区| 蜜桃在线一区二区三区| 国产,欧美色淫一区二区| 欧美爽歪歪一区二区三区| 国产,亚洲,欧美一区二区| 长篇亚洲欧美一区经典| 殴亚日韩一区二区三区| 国产欧美一区二区三区综合野| 欧美精品一区二区在线观看| 韩国主播福利一区二区二区三区| 青青草app色版网站免费| 欧美一区二区三区四五六七八 | 野花香视频社区在线| 欧美黄色一级手机免费资源| 欧美精品一区二区三区关看| 欧美女优一区二区三区| 欧美日韩一区二区三区四区 | 欧美美女性xx一区二区| 玖玖资源网影音先锋| 麻豆一二三四五六区| 欧美高清在线一区二区三区四区| 欧美日韩福利一区二区| 精品女同一区二区三区G下载| 国产欧美一区二区三区高清不卡| 欧美尼龙丝足福利视频一区二区| 欧美日韩岛国一区二区三区 | 欧美国产精品一区二区| 欧美美女黄一区二区| 亚洲成人骚网站浏览| 欧美一区二区三区四区五区| 欧美成人一区二区三| 欧美操屄精品一区二区三区| 青青草APP污污污免费下载苹果| 男生露jiji秘免费网站| 高清1区2区3区4区产品| 欧美日韩高清一本道| 蜜芽中文字幕一区二区| 亚洲成人社区1区2区| 国产福利视频一区二区三区| 麻豆转煤官方网站入口| 欧美狂野一区二区三区| 色窝窝华人社区下载| 色婷婷免费情趣视频| 欧美视频啪啪啪一区二区| 自慰片亚洲一区二区三区| 欧美德国双飞淫二区| 欧美一区二区三区免费入口| 亚洲成人性爱一区二区| 自由色XXⅩ业余自由视频网下载| 国产成人短视频观看| 欧美高清视频三区四区| 特美1级aa免费。| 黃色成人大片色大师下载免费| 欧美大黄一级片免费的| 欧美一区二区三区三级影视| 国产欧美黄乱绿一区二区三区| 国产精品亚洲综一区二区| 欧美黄色精选视频一区| 激情一区二区三区。。。。| 本一区二区三区中文字幕| 舞蹈老师在线免费观看精品1区| 欧美日韩国产精品2025| 欧美婷婷一区二区三区| 国产欧美成人一区二区二区| 韩国日本免费观看mv软件的优势| 欧美私人+一区二区| 精品网站人妻一区二区三区蜜桃| 神木丽在线一区二区三区| 色呦呦呦呦呦呦呦呦呦呦呦| 男人天堂网在线观看| 翔田千里一区二区亚洲| 美国成人动漫AV一区二区| 欧美成人一区二区野外| 黄网站在线永久免费观看| 精品成人亚洲中文字幕| 青青草APP污污污| 亚洲成人天堂视频一区| 精品欧美一区二区三区| 欧美精品性爱二区三区| 铃木心春一区二区三区| 香港亚洲非洲三级网站| 欧美视频一区二区App下载| 男女做爰全免费A片色戒App| 国产乱码精品一区二区三区视频下载 | 黑人AV一区二区三区| 欧美愉拍一区二区三区| 欧美福利视频一区二区| 麻豆传媒免费视频下载网址| 欧美私人+一区二区| 美女主播自摸一区二区三区| 黄色网一区二区三区| 黄页网站18以下勿看| 欧美在线一二三四区| 欧美高清另类一区二区三区| 熟女少妇丰满一区二区视频软件 | 色欲AV天天堂综合一区二区|| 麻豆欧美一区二区三区| 狂野欧美一区二区三区四区| 精品码产区一区二精工厂| 黄偏免费网站daquan| 欧美性爱网一区二区| 男生露jiji网站| 艳色歌舞团一区二区1| 黄色小说成人电影在线免下载| 牛牛影视精品一区二区在线看| 精品麻婆豆腐一区二区| 美女推油一区二区三区| 欧美一区二区三区少妇熟女| 欧美熟女一区二区免费| 温泉媚药一区二区三区| 欧美特区一区二区三区| 精品一曲二曲三曲四| 涩婷婷成人电影观看| 男人天堂手机在线观看| 欧美激情一区二区三区p站| 男人天堂手机在线视频| 色窝窝无码一区二区三区成人| 麻豆精产国品一二三产品| 欧美一区二区三区五月激情| 国产成人精品一区二区| 欧美一二三四手机在线观看| 黑人猛欧美一区二区三区| 色欲www成人网站| 国产亚洲一卡2卡3卡4卡网站| 亚洲天堂视频网苹果| 亚洲天堂网站APP| 桔色综合亚洲一区二区三区| 青草视频www成人网站下载| 颤抖小蜜桃成人网站| 污污视频网站观看平台| 香蕉AV一区二区三区| 特黄特色大片免费观看播放器 | 国产精品欧美分区| 黄色一区二区三三区| 香蕉久久免费不卡一区| 理伦一区三区美国亚洲| 美女黄黄黄黄黄网站| 韩国主播一区二区欧美| 亚洲成人性爱一区二区| 麻豆秘视频一区二| 欧美一区二区三区性精品| 色婷婷一月在线视频| 精品久久久久久久蜜桃无码| 亚洲成人抖音快手精品三级| 永久免费AV无码蜜桃网站| 欧美一区二区三区囗交囗爆| 精品欧美视频一区二区| 都市亚洲校园一区二区三四| 欧美精品在线播放四区| 欧美短视频精品二区| 2025国产最新无码精品| 爽歪歪一区二区三区四区五区| 亚洲成人黄色电影一区二区| 男女久久久久久久蜜桃| 欧美搞操一区二区三区| 欧美成人精品一区二区男 | 欧美黄片二区一区色色| 韩国美女区一区二区| 玖美成人一区二区三区| 欧美城人精品一区二区三区| 欧美色欧美亚洲另类一区二区三区 | 男女交配视频应用下载中心| 殴美国产视频一区二区| 欧美国产精品第一区第二区| 欧美性做爰全过程免费| 欧美黑粗直成人一区| 欧美性精品一二三区| 国产不卡不卡一区二区| 亚洲成人看片一区二| 蜜桃一区久久久久| 欧美一区二区在线播放| 欧美高清激情一区二区| 国产日本欧美一区二区bt下载| 欧美韩日国产人妖制服 | 桃色成人在线亚洲一区| 欧美无砖专二区二中文字| 国产精品主播一区二区主播| 亚洲成人播放器视频亚洲色| 美女的隐私秘部位网站免费| 欧美日韩一区二区污| 欧美性爱在线一区二区| 色花堂98一区二区三区| 麻豆成人传楳一区二区| 欧美无砖区一中文字| 色婷婷成人做爰A片免费看网站 | 欧美牲交一区二区三区| 超碰成人地址一地址二| 精品欧美区一区二区三区四区| 欧美金典成人一区二区| 美女流出大量的白浆推特免费下载 | 欧美独立网站一区二区| 野花香日本大全免费观看| 亚洲成人小说网站20245免费不要钱在线观看下载| 欧美成人影片一区二区| 青青草app成人看片软件| 欧美jiZZ18性欧美| 蜜桃九九九九一二三区| 国产一区二区三区天海翼| 欧美在线亚洲app| 精品人伦一区二区三区蜜桃牛牛最新版本 | 欧美一区二区三区色| 亚洲成人一区二区二区| 欧美一区二区三区三区| 欧美一伦一情一色网站| 欧美精品黄色一区二区| 蜜桃免费视频一区二区| 色欲欲WWW成人网站| 殴美成人伦理一区二区三区| 黑人精品巨大一区二区三区兔费| 麻豆视传媒app官方在线看| 黑巨人精品一区二区三区| 国产成人综合亚洲专区| 殴美国产视频一区二区| 蜜桃臀专区一区二区| 美日韩一区二区三区四区五区六区手机免费 | 欧美激情一区二区三级高清视频| 波多手机在线一区二区| 麻豆转煤官方网站入口| 精品熟人一区二区三区四区| 欧美一区二区三区性爰| 麻豆视传媒短视频最新网址入口| 黄色一级片日本一区二区| 亚洲成人小说网站20245免费不要钱在线观看下载 | 国产成人综合亚洲亚洲欧美| 蜜桃传媒一区狼人综合干练| 欧美一区二区高清| 韩欧美视频在线一区| 欧美性视频一区三区| 欧美精品第一区二区| 香娇九九九福利导航 | 麻豆国产传媒一区二区| 欧美国产日韩分区一区二区| 欧美手机一区二区三区| 欧美一区二区三区四区五区〖网: 欧美一区二区三区四区五区〖网:.〗 | 清纯唯美五月丁香婷婷综合| 亚洲成人一区二区二区| 色资源欧美三区六区百度网盘| 欧美淫妇一区二区三区| 看片网一区二区免费下载| 麻豆传媒入口2023| 香蕉黄色色欲网站App| 欧美成人三区二区一区| 欧美性爱一,二,三区| 神木丽无码START-326| 欧美成人色图一区二区| 国产欧美精品一二三四区| 欧美精品一区、二区| 欧美淫荡妇一区二区| 黄色亚州一区二区三区| 欧美日韩在线观看一区二区三区在线观看App下载 | 欧美性丝袜一区二区| 湖南一区二区三区网站| 色窝窝手机在线视频| 殴亚日韩一区二区三区| 男男自慰18禁网站| 韩国日本欧美视频二区| 国产伦精品一区二区三区男技| 欧美激情视频一区二区三区三州李冰冰| 福利欧美一区二区| 黑人一区二区三区视频| 欧美一区二区三区四区五区在干嘛呢? | 亚洲成人AV免费播放器| 美女的隐私部位2025下载免费视频软件| 欧美激情乱伦一区二区三区| 视频号一区二区视频| 黄色这里只有2025| 欧美成人精品一区二区三区毛片| 2025亚洲无码视频| 美女的隐私部位网站| 亚洲成人综合在线一区| 欧美成人精精品一区二区频| 永久黄区观看在线网址| 黄网站免费永久在线观看下载| 白白发布免费在线播放视频| 欧美精品在线一区二区三区| 老司机永久免费看片| 欧美日本韩国一区二区三区不卡| 欧美一区二区三区一级片| 国产成人十亚洲十欧州十综合 | 鸥美成人老司机叉叉叉| 美女扒开腿秘男人爽桶| 蜜乳一区二区三区中文字幕 | 亚洲手机热产中文无码| 欧美精品系列一区二区三区| 欧美一区三区三区高清不卡 | 国产日韩高清欧美专区| 欧美激情一区二区加勒比| 网站你懂我的意思吧在线观看下载| 色呦呦欧美二区三区| 欧美日韩成人软件下载免费| 韩国禁片网站下载安装| 西瓜m3u8成人网站| 国产做受高潮短发| 色欲亚洲精品一区二区| 综合杏色影视丁香五月婷婷| 色老板免费视频区二区| 色窝窝无码精品一区二区 | 理伦一区三区美国亚洲| 欧美视频在线二区| 欧美一区二区三区爽歪歪| 欧美一区二区三区性视频| 韩日欧美一区二区精选视频| 欧美黄色app下载| 激情亲热视频一区二区| 熟妇一区二区蜜桃视频| 青青草原一区二区三区四区蜜桃 | 经典再现一区二区三区| 精品秘一区二三区胖子| 欧美激情一区二区三区亚洲视频声音太大| 国产一区二区福利片| 亚洲成人在线输出位| 精品欧美专区一线二线| 色婷婷777777777| 欧美性爱一,二,三区| 欧美一区二区三区色情| 欧美色小说一区二区| 锕锕锕锕锕锕锕锕锕锕好| 欧美在线一区二区观看| 香蕉av蜜臀av一区二区| 2025年最新妞干网| 欧美一区二区三区不卡在线| 男生露jiji秘网站免费下载| 让岳怀孕一区二区三区| 足疗店双飞女技师一区二区| 欧美一区二区三区爽歪歪| 国产成人欧美一区二区三区的| 麻豆传煤网站APP入口直接进入免费版| 国产亚州欧美一区二区三区| 国产J8又粗又硬又大| 精品女同一区二区三区G下载 | 海角社区在线视频播放观看| 麻豆精东一区二区| 殴美geeexx一二三区| 水蜜桃福利一区二区三区| 欧美精品激情A片免费区酒店| 欧美日韩一区二区不卡| 男生露jiji秘免费网站| 自拍视频一区视频二区| 欧美视频图片一区| 欧美性爱人兽一区二| 麻豆文化传媒官网最新| 欧美日韩中一区二区| 欧美综合激情一区二区| 麻豆传播媒体免费版官网| 2025国产一级精品| 欧美精品一区二区三区插入| 综合久久久久综合综合久…| 欧美日韩综合一区二区| 2025年最新成人网站| 欧美性爱一区三区三区| 欧美激情综合一区二区| 色八戒一区二区三区| 香蕉av久久一区二区三区AV| 精品人妻一区二区三区鲁大师| 欧美日本一区二区爽爽爽| 欧美日韩一区二区qqq| 蜜桃A综合一区二区| 2025国产精品久久久| 欧美模特双飞一区二区AA| 男人的最新版天堂视频网站| 鸥美无码一区二区三区| 男人露jiji视频网站| 糖果99999一区二区| 欧美一区二区三区四区五区〖网:.〗 | 特级欧美婬片免费高清| 犬香蕉一区二区三区| 熟妇一区二区三区四区卡| 亚洲成人在线免费福利| 男人天堂网夜色99视频| 欧美一区二区三区按摩在线| 欧美激情视频一区二区三区四区 | 国产亚洲欧洲一区二区| 欧美成人精品在线观看下载| 亚洲无矿专区2025| 精品不卡一区二区高速| 男人露jiji秘视频网站| 亚洲影院一区二区三区| 欧美熟女一区二区三区| 欧美无砖一中文字目复| 欧美一区不卡午夜成人| 欧美成人精品A片免费区| 欧美激情一区二区三区不卡视频| 欧美黄色一区不卡在线| 欧美性爱一区二区三区| 黄色片网站现在免费安装 | 欧美一区不卡午夜激情成人| 色窝窝视频在线观看| 美国精品毛毛片一区二区| 韩国午夜福利一区二区| 国产福利视频一区二区三区 | 香蕉精品二区二区三区四区五区| 欧美性交一区二区三区| 亚洲成人综合一二区| 国产区颜值巅峰探花大神| 香蕉狼人一区二区三区四| 欧美黄色精品一区二区| 色帝国欧美在线二区| 极品少妇一区二区三区| 欧美清晰一区二区三区| 欧美州处破在线不卡| 2025亚洲天堂无码视频手机版| 黄网站app免费大全中国| 国产伦精品一区二区三区妓女下载安装| 风流老熟女一区二区三区 | 国产探花精品一区二区| 欧美视频一区视频二区| 欧美精品一区二区午夜激情| 欧美一区二不卡视频| 国产一区二区三区亚洲一区二区三区欧美 | 狠狠撸一区二区三区| 国产一取二区三区成人| 色丝袜欧美一区二区| 男人露jiji秘免费视频网站麻豆| 欧美激情一区二区| 蜜桃臀视频一区二区| 色撸撸一区二区三区果冻| 青青免费视频下载方法| 欧美一区二区三区四区短视频| 2021亚洲砖码专区| 欧美成人一区二区野外| 欧美日韩亚洲中文字幕直播软件| 欧美一区二区三区水牛视频| 黄色.comsjfh| 欧美大片黄精品一区二区| 欧美激情一区二区三区公司 | 蜜桃香蕉精品一区二区| 激情yiquerqu| 欧美成人精品一区二级V| 狂野欧美久久一区二区| 欧美色色一区二区三区四区丝袜| 殴美熟女一区二区三区| 国产免费一区二区三区色大师| 精品VS欧美一区二区三区| 樱桃视频一区二区三区| 国产91眼镜对白在线播放| 黄色视频污污软件老司机| 欧美一区二区18P| 香蕉久久aⅴ一区二区三区| 蜜桃Av夜色网站免费版| 欧美vs电影免费一区二区| 青苹果一区二区三区| 欧美成色手机在线综合| 2025国内精品。| 色偷偷亚洲一区二区三区| 精品一区二区三四区| 麻豆文化传媒app网站| 色哟哟一区二区三区四区 | 国产做受高潮短发| 熟女温泉不伦一区二区| 黄色.comsjfh| 网页升级通知欧美另类成人| 金品一区视频怎么下载| 欧美精品不卡一区二区| 男人叉b的动态图片| 馒头大胆亚洲一区二区| 亚洲成动漫一二区蜜桃| 国产91边对白在线播放| 精品一曲二曲三曲四曲五曲区 | 欧美日韩三区四区肉便器| 欧美理论在线一区二区情侣| 国产亚州欧美一区二区三区| 欧美一区二区三区激情视频| 欧美一区家庭校园亚洲| 欧美成人性色生活一区二区| 国产欧美一区二区三区综合野| 欧美日韩人人精品牛牛影视| 欧美宗合另类色亚洲| 男人添女人荫道口视频| 男生露jiji秘中国| 欧美多阴毛女性视频一区二区| 欧美禁区一区二区三区| 熟女熟妇AV网站密桃| 欧美精品一区二区三区欧美性啊| 男人的天堂最新地址| 激情文学亚洲一区二区三区| 欧美激情一区21P| 欧美性爱一区-二区| 欧美性猛交一区二区三区精品技师| 香蕉视频一区二区三区| 激情欧美一区二区三区黑长吊牛牛影视 | 熟女人妻一区二区三区四区在线看| 欧美激情一区二区三| 欧美黑白配一区二区三区| 法国精品一区二区在线| 蜜桃一区二区蜜桃一区| 香蕉久久久久久久久久女人天堂一品| 欧美在线观看一区二区| 欧美日韩国产综合新一区| 欧美精品一区二区三区四区五区| 欧美无人矿一区二区| 欧美性爱一区二区视频| 黄色内射一区二区三区| 色色资源免费服务平台欧美性爱三区 | 韩国色情一卡二卡三卡| 欧美成人黄片网站,免费| 色欲欲www成人网站视频| 色综合色综合婷婷热| 欧美一区二区三区嗯嗯啊啊啊嗯嗯| 综合亚洲中文在线一区| 欧美第一区在线观看视频| 精品伦子一区二三区| 高清无码日本成人漫画| 欧美短视频一区二区| 国产偷窥猎奇福利二区| 国产99成人精品视频免费福利| 艹1逼好奇.com+| 网站一区二区肛欧美| 网站污app免费看| 色婷婷在线视频小树林| 欧美一区二区三区激情无套| 亚洲成人观看APP下载网址| 色综合色综合婷婷热| 麻豆传媒入口免费进入| 野花香社区色狼视频| 欧美性爱在线一区二区| 欧美老BBBXXXxX| 欧美熟女女优一区二区| 国产91边对白在线播放| 国产在线不卡卡卡不卡卡卡| 荷兰视频一区二区三区| 高清欧美亚洲一区二区| 色哟哟免费视频观看,在线观看不收费| 美国人性激情一区二区三区| 欧美激情视频在线观看一区二区| 欧美国产精品一区二区三区 | 欧美激情一区二区三级高清视频 | 欧美一区二区三区88| 欧美黄色精选视频一区| 亚洲成人网址app大全| 翔田千里一区二区三区久久| 亚洲成人在线观看app| 亚洲天堂无码在线推特大神| 美女18禁免费看视频APP| 国产欧美精品一区二区三区| 欧美玲传媒亚洲精品在线一区二区三区 | 欧美色欧美亚洲另类七区| 欧美家庭成人一区二区| 网友自拍欧美激情视频区| 越南樱桃成人综合一区二区| 欧美视频VIDEO一区二区| 精品欧美一区二区成人| 西野工刂力欧美二区| 欧美成人午夜一区二区三区| 熟女露脸一区二区三区| 美国黄色高清一区二区三区| 欧美一区二区三区综合cn| 熟女视频一区二区三区三| 美女隐私黄色色情网站一区二区三区在线下载 | 欧美在线亚洲社区一区| 老司机精品成人免费视频下载| 欧美精品电影一区二区| 欧美精品一区二区地狱猫| 老头添女荫道口免费播放| 欧美情色一区二区三区| 欧美激情视频一区二区三区三州李冰冰 | 综合avtt天堂导航| 熟女极品视频一区二区| 麻豆传媒影院一区二区| 麻豆视传媒短视频网站-入口2021仙踪林 | 亚洲成人网址app大全| 亚洲天堂网2023| 国产日韩粉嫩一区二区| 欧美新一区二区三区| 韩国成人一区二区三区| 欧美一区二区三区嗯嗯啊啊啊嗯嗯| 欧美一区二区| 玉蒲团中文字幕一区二区| 欧美一二区在线观看短视频| 2025成人在线看| 蜜桃传媒在线一区二区| 香蕉日日精品一区二区三区四区五区| 欧美基情一区二区三区| 老头天堂黄色视频网站| 粉嫩一区二区三区四区五区| 黑人精品系列一区二区| 欧美日韩香蕉一区二区| 欧美多人在线一区二区| 蜜桃午夜精品一区二区| 亚洲成人精品AV一区| 英国一区二区三区成年人都| 欧美一区二区三区四区二百| 国产日韩欧美一区精品苹果| 色老板一区二区三区| 美国一区二区三区AV| 激情综合婷婷丁香五月| 极品自慰一区二区三区| 黄avapp网站| 美国一级大黄一片免费的网站| 欧美成人免播放器视频| 欧美成人影片手机版| 欧美日韩综合一区二区 | 男人天堂手机版免费在线视频| 污污污免费网站下载| 欧美成人精品一区二区三区视频下载| 黄页网址大全av下载| 色婷婷黄色特级网站| 美国一区二区三区视屏| 黄色二级成人网站下载| 豆花视频亚洲一区二区| 男女人裸体性做爰视频| 欧美一区二区三区五月激情| 色狠狠一區二區三區香蕉| 麻豆传媒视频一二三区| 精品一区二区三区亚洲有限公司| 国产痴汉系亚洲一区| 国产欧美一区二区三区hd| 精品免费产品日亚韩精品| 国产真人无码性教育片| 老司机成人福利视频| 麻豆传媒一区在线天堂岛| 亚洲成人欧美国产一区| 国产又爽又黄免费下载| 欧美一三区在线不卡| 欧美激情办公室一区二区| 国产福利一区二区三区在线视频| 欧美视频手机在线一区| 精品一区三区三区半夜| 欧美激情一区二区三区四区五区| 国产亚洲精品久久久网站好莱| 潮潮久久久精品一区二区| 欧美日本亚洲一区二区三区| 国产精品一区二区推荐| 欧美成人H版阿拉丁色情版| 国产一区二区三区一个人| 欧美激情黑白配一区二区三区| 红桃在线一区二区三区四区| 水蜜桃黄色成人网站| 国产探花自拍偷拍一区二区| 色欲网址App下载| 国产海角社区视频在线看| 精品一区二区三区四| 辉月あんり亚洲一区二区| 欧美视频在线二区| 激情欧美一区二区三区黑长吊牛牛影视 | 色老头在线免费视频| 蜜桃传媒一区二区亚洲网站| 欧美日韩国产一二区色播| 麻豆实验室一区二区精品蜜桃免费看| 欧美性感视频区一区二| 欲望色香淫色天天影视| 美女黄视频软件免费下载| 色哟哟一一免费观看| 熟富婆一区二区三区啪啪TV | 色女人视频播放平台| 男人露jiji秘免费视频樱花| 麻豆视传媒短视频网站安卓入口| 欧美强黄色一区二区| 欧美精品一区二区午夜激情| 黄页网站大全在线免费观看| 欧美大片黄精品一区二区| 欧美日韩精品一二区| 欧美服日韩中文字幕制服| 色偷偷男性亚洲一区二区| 欧美黄色一区不卡在线| 欧美成人乱码一区二区| 欧美熟女啪啪一区二区| 欧美多人片高潮野外做片黑人| 美国一区二区欧美亚洲| 欧美成人综合中文网| 亚洲天堂网站红桃| 菠萝蜜一区二免费进免费| 欧美综合精品一区二区高跟鞋 | 国产一区欧洲一区二区| 色婷婷图片视频成人福利| 美国一区二区在线观看| 色花堂98一区二区三区| 欧美成人怡红院一区| 蜜桃午夜精品一区二区| 美女隐私部位无遮盖免费看| 欧美精品一区二区三区嫩模| 欧美日韩国产综合新一区| 亚洲成人一区小说,偷拍韩国二线女明星晚上的兼职-巧露AV♂♂ | 欧美清晰一区二区三区| 韩国欧美日本一区二区三区| 色成人网站在线免费抖音ww| 欧美日韩国产综合剧情一区二区| 欧美成人精品一区推荐| 欧美一区二区三区性爱网| 那里可以免费下载A片| 欧美一区二区三区水牛影视| 欧美一区二区三区午夜激情| 欧美色一区二区三区四区五区六区| 欧美极品白浆一区二区| 青柚蜜桃探花一区二区| 欧美激情网一区二区| 欧美国产日韩精品蜜yp| 涩婷婷成人电影观看| 亚洲开放成人水蜜桃网站| 波多野结衣一区二区三区四区下载| 精品人妻无码一区二区三区葡京| 欧美激情一区二区粉嫩| 欧美一区二区三区熟女| 欧美电影在线亚洲一区| 欧美视频三区图片区| 海角社区免费视频播放| 黄本子视频网站在线看| 欧美一区二区三区爱爱| 神马亚洲欧美一区二区三区| 色呦呦在线观看入口| 欧美精品一区二区三区很无很色的| 亚洲天堂日本社区网| 欧美女同对干在线一区二区| 欧美色图片一区二区| 亚洲成人看片一区二| 欧美精品一区二区少| 美洲天堂一区二卡三卡四卡 | 色窝窝视频在线观看| 韩国成人网站漫画无码| 精品免费产品日亚韩二三区| 欧美成人一区二区冫| 调教欧美视频免费播放| 私人成人亚洲一区二区| 精品一区二区三区网站| 欧美v亚洲v日本| 欧美成人电影1区2区| 视频区图片区小说区综合色区| 欧美一区二区三区四区啪啪| 男男免费看,十八禁| 韩国爆乳内射免费一区二区| 美国毛片一区二区三区更新| 亚洲天堂无码在线推特大神| 亚洲成a人片77777kkkk1| 茄子视频一区二区在线观看| 欧美日高清一区二区三区| 深夜成人电影天堂亚洲一二三区| 色哟哟网站在线免费观看| 欧美一区二区三区夜夜嗨| 欧美日成人一二三区| 亚洲无码高清下载| 欧美一区二区三区综合色| 欧美自慰在线应用一区二区三区| 粉色91视频在线免费观看| 特黄特色特爽免费视频| 私房KTV视频在线一区| 美女隐私部位秘免费网站 | 欧美激情视频第一区| 欧美日韩亚洲一区二区三区四区免费 | 欧美日韩亚洲一区三区| 麻花豆剧国产MV在视频播出| 国产成人综合电影专区| 欧美一区三区三区高清不卡| 欧美家庭成人一区二区| 欧美精品一级二级三级四级五区六区| 欧美视频免费观看一区二区三区 | 综合社区亚洲欧美| 激情欧美一区二区三区黑长吊 | 欧美视频三区图片区| 欧美日逼网一区二区| 精品国产不卡一区二区| 美脚恋足亚洲精品一区| 精品麻婆豆腐一区二区| 美国一区二区在线播放| 萌白酱精品一区二区| 香蕉久久AV一区二区三区| 欧美日韩一区三区二区综合| 国产嫖妓一区二区三区| 韩国女主播福利一区二区三区五区| 亚洲成在人线综合导航下载全集免费| 欧美一区二区三区四区五区〖网:.〗 | 欧美日韩国内一区二区| 黄色外国视频一区二区| 欧美黄色操b一二三区| 老司机色情免费安装| 激情综合一区二区三区| 西野工刂力欧美二区| 狂吻胸视频网站免费观看下载| 国产精品一区二区三区欧美一区| 色欲综合一区二区三区| 美女18网站app| 涩色网站.com391| 男人露jiji秘免费视频网站麻豆| 欧美高清一区二区三区三州| 欧美清晰一区二区三区| 美国精品性色一区二区| 欧美成人免费播放器| 欧美精品区一区二区三区四区| 欧美高清视频不卡一二区| 殴美一区二区三区享享| 视频中文字幕一区二区三区| 国产欧美一区二区三区hd| 网页升级访问日韩一区| 国产欧美日韩一区二区三区四区| 欧美一区二区三区爽一级鸡巴草逼| 污污网站视频观看大全免费| 国产亚洲一区=区三区| 欧美精品一区二区三区四区合区| 欧美精品美利坚一区二区三区| 欧美成人淫秽破处一区二区| 精品人妻无码一区二区三区葡京| 欧美一区二区三区免费看教程 | 麻豆视频_抖音传媒| 精品熟人一区二区三区四区| 欧美精品无码不卡一区二区三区 | 欧美黄性视频一区二区三区| 欧美一区二区三区爽爽爽| 深夜福利亚洲一区二区三区| 非洲人欧洲人社区一区二区| 欧美成人久久一区二区| 迷情校园都市激情亚洲一区二区| 欧美成人制服诱惑一区| 欧美激情一区二区在线观看-90分钟完整版最新电影迅雷下载 | 精品女同一区二区三区G下载 | 亚洲情艺中心成人网站| 苍井空AV2025中文字幕| 欧美成人精品二区三区| 国产亚洲美国一区二区三区| 色哟哟免费视频观看,在线观看不收费| 欧美性爱一级片一区二区三区| 欧美精品欧美一区二区三区| 欧美日韩最新一区二区| 韩国一二三区自拍偷拍导航| 欧美色播1218| 欧美爱爱爱一区二区三区| 欧美在线精品一区二区三区 | 欧美激情二三区视频| 相泽南二区三区下载| 国产av一区二区三区破解软件| 欧美高清视频一区二区三区四区| 男人的天堂AVAPP| 欧美一区二区三区不卡在线| 色哟哟哟一区二区一| 页面正在升级欧美一区| 麻豆含羞草一区免费进入| 禁精品一区二区三区三州府| 欧美成人一级_亚洲国精产品| 欧美精品无码不卡一区二区三区 | 国产精品一区二区午夜福利| 桔色综合亚洲一区二区三区| 本网站亚洲一区二区| 韩日老撸友一区二区| 欧美日韩一区二区三区色欲a√ | 欧美一区二区三区四区视频| 欧美日本一区二区在线观看| 国产伦精品一区二区三区下载 | 麻豆天美糖心一区二区| 欧美视频免费一个区二区三区| 美女少妇无遮挡网站在线观看视频下载 | 欧美一区二区三区水牛影视| 黑丝一区二区三区,| 熟富婆一区二区三区啪啪TV| 趁人网站亚洲中文| 黄网站在线永久免费观看| 绝色av亚洲一区二区| 黄色亚洲一区二区三区| 国产成+人+亚洲+欧美综合,| 网友自拍欧美激情视频区| 亚洲成人色穴一区二区| 亚洲天堂无码一区二区| 麻豆精产国品一二三区别软件| 网红主播福利一区在线观看| 欧美精品一区二区在线| 欧美日韩无砖专区一中文字| 欧美一区二区三区整片| 综合欧美国产一区二区三区| 激情内射日本一区二区三区,| 欧美激情一区二区视频免费下载观看| 亚洲成人欧美一区二区| 金8天国一区二区三区| 欧美影院一区二区三区| 欧美大香蕉伊思一区二区| 粉色影院精品一区二区欧美激情| 欧美综合色区手机版| 精品推荐主播一区二区三区不骗 | 骚逼情骚逼一区情侣二区| 亚洲成年人一区二区| 2025四虎最新网址| 美女的隐私直接进入免费网址| 欧美日本一区二区在线播放| 欧美成人一区二区,| 2025年最新色情网站| 贵妇交换一区二区三区| 欧美精品1区2区3区| 欧美一区二区三区不免费| 苍井空无码破解日B网| 欧美独立网站一区二区| 老人添女荫道口视频| 秋霞视频成人app观看| 亚洲无码2023砖区| 爱爱一区二区久久香蕉| 韩国一区二区三区视频| 网站你懂我的意思吧在线观看下载| 欧美一区二区三区四区成人影视| 精品欧美一区二区三区四区五区六欧夂攵| 亚洲天堂黄色按摩店| 黑牛成人一区二区三区影院 | 欧美大香蕉一区二区| 爱爱一级爱一级爱一级棒| 黑人久久一区二区三区| 白鹿的隐私秘免费视频| 苹果免费亚洲视频成人| 亚洲成人码一区二区| 高HH写真视频网站免费看| 欧美日韩精品一区二区香蕉下载| 老汉色一区二区三区| 韩国三级电影一区二区下载| 视频一区++啊++啊++啊++啊+啊啊啊| 欧美精品一区二区APP| 精品媚药一区二区三区四区| 黄色精品网站在线下载| 福利视频一区二区三区四区五区 | 欧美国产精品区一区| 欧美一区二区三区激情视频| 色综合色综合婷婷热| 欧美大码一二三区免费| 欧美xxxxx成人| 欧美在线一二三四区| 美女18网站app| 黄色免费www..com| 欧美成人精品一区二| 欧美熟妇色图一区二区| 欧美永久激情一区二区| 精品成人一区二区三区四区| 老司机深夜开车一区二区三区| 欧美激情另类一区二区| 粉嫩av一区二区三区天美传媒 | 美国一级片软件下载| 欧美美激情一区二区三区| 色情网站免下载观看| 欧美留学生一区二区在线视频| 欧美激情四射一区二区三区| 亚洲成人一区小说,偷拍韩国二线女明星晚上的兼职-巧露AV♂♂ | 蜜桃一二三四五区的视频| 福利一区二区三区艹| 精品偷拍一区二区三区在下载 | 欧美美女一区二区三区成人美一区 | 污污网站视频观看大全免费 | 欧美布兰迪一区二区| 欧美日韩福利一区二区| 熟女熟妇一区二区三区| 欧美在线一区二区在线视频| 精品巧妇一区二区三区四区五区| 欧美尼龙丝足福利视频一区二区 | 国产欧美一区二区三区另类精品 | 欧美精三区欧美精三区| 欧美精品一区=区三区四区| 欧美一区,二区,三区成人祝频 | 亚洲按摩一区二区三区| 国产成人在线播放视频| 欧美日韩国产精品一区二区三区四区五区 | 亚洲成AV人片一区二区| 欧美经典精品一区二区| 欧美国产香蕉一区二区| 国产欧美亚洲一区二区| 网站懂我意思吧视频在线观看| 黑人干白人三级一区二区| 色婷婷一月在线视频| 欧美性爱二区三区四区| 牛牛电影国产一区二区| 欧美精品黄色一区二区| 亚洲天堂色情天堂一区| 青青草视频TV成人版| 欧美激情在线片一区| 鲁丝成人一区二区三区影院| 麻豆成人入口即化地址| 亚洲影音先锋一区二区三区| 黄色a毛网站免费下载| 麻豆经典VS传文化| 欧美色精品一区二区| 欧美一区二区三区免| 真人无码性教育片mp4| 黑人巨大精品欧美一区二区免费 | 欧美成人在线成人一区| 精品一区二区三区网站| 国产伦精品一区二区三区妓女下载安装 | 翔田千里一区二区三区久久| 亚洲愉拍一区二区三区| 美国一级大黄片久久久 | 欧美成人在线成人一区| 欧美一区二区三区中文子幕 | 视频一区无码破解| 国产成人欧美成人在线观看| 色哟哟网站在线免费观看| 欧美vs电影免费一区二区| 欧美一区二区三区四区婷婷| 欧美日韩香蕉一区二区| 欧美非乱伦一区二区| 麻豆精产国品一二三| 欧美日韩一区二区污| 色窝窝无码一区二区三区成人| 色窝窝免费播放视频| 欧美激情一区二区三区p站| 精品一区二区三区亚洲有限公司| 麻豆回家视频一区二区| 欧美一区二区三区熟女| 欧美精品一区二区三区亚裔| 青青草app色版网站| 欧美日韩黄色电影下载| 美女扒开腿秘男人爽桶| 欧美精品在一区二区三区| 蜜美杏一区二区三区| 欧美操屄精品一区二区三区| 欧美视频成人小说漫画一区二区| 精品欧美一区二区中文字幕视频| 欧美一区二区三区成践| 欧美视频一区二区三区| 欧美色吧专区另类欧美色吧专区| 激情国际一区二区三区| 极品露脸一区二区蜜桃| 精品一区三区三区半夜| 老人添女荫道口视频| 精品熟女一区二区三区| 香蕉av久久一区二区三区| 欧美日韩亚洲另类综合体| 欧美激情视频在线观看一区二区| 欧美老牛影视A√成人一区二区三区四区 | 欧美大奶子艹逼一区二区三区| 精品人伦一区二区三区闺蜜| 欧美精品无码一区二区三区19 | 老司机福利appios| 锕锕锕锕锕锕www湿透了网址| 欧美一二三区顶级视频| 亚洲成人视频手机版| 精品人伦一区二区三区闺蜜| 欧美一区二区中文视频| 欧美大片一区二区三区| 国产一区二区中文字幕| 国产成人综合亚洲亚洲欧美| 黄黄黄黄黄黄黄黄黄黄一区二区三区四区| 2022亚洲成色网站上| 欧美一区二区三区精海角| 国产一线二线三线成人网站| 涩涩网站在线免费下载| 精品蜜桃一区二区三区| 欧美视频网站一区二区三区| 亚洲成人国产一区二区撸大师 | 野花香社区TV在线| 美女欧美黄色一区二区| 欧美生活区一区二区,三区| 欧美高清一区二区三区三州| 蜜桃永久视频在线一区二区三区| 韩国一区二区大香蕉| 翔田千里一区二区三区久久| 色八戒国产一区二区三区| 牛人盗摄一区二区三区视频| 欧美精品一区二区中文无码| 男人射精视频app| 欧美成人a62v免费视频| 美国一区二区无视频| 欧美成人性爱一级黄| 国产一线二线三线女装品牌| 苍井空无码去哪里下载| 精品线路一区二区| 亚洲成人在线免费福利| 亚洲天堂综合另类v| 欧美性爱综合一区二区三区| 特色特黄视频免费观看| 亚洲成a人片77777kkkk1| 白虎白丝亚洲一区二区| 国产成人+综合亚5| 殴美激情视频一区二区三区| 黑人巨大精品欧美一区二区免费| 20251009亚洲无码| 说这老娘们国产丁香5月丁香5月丁香综合国产| 精品人妻一区二区三区鲁大师| 麻豆AB一区在线观看| 殴美野战一区二区视频| 国产精品中字一区二区| 特黄特色大片视频免费播放软件| 亚洲成人黄色第一二区| 皇家华人一区二区三区| 黑人精品巨大一区二区三区兔费| 美女隐私网站直接免费观看| 欧美曰韩综合一区二区三区| 美女全黄免费看网站| 色窝窝视频在线观看| 美国欧洲无码一区二区| 亚洲天堂日本社区网| 正在播播不卡的一区二区| 美女网站18在线观看| 粉嫩欧美一区二区三区| 欧美男女激情精品一区| 色哟哟网站在线免费观看| 麻豆传媒官方官方网址| 歐美精品一區二區三區四區| 欧美日韩激情一区二区| 欧美老BBBXXXxX| 网站你明白我的意思吧免费| 色资源欧美三区六区百度网盘| 黄色网址在线观看下载观 | 歐美一區二區三區在綫視頻| 黄色网址在线观看免费下载地址国产 | 蜜桃诱惑肥臀主播一区| 欧美一二区激情视频| 欧美一区二区三区操| 黑巨人精品一区二区三区丰满| 欧美精品高清免费一二三区| 给我一个人最新色情网站| 黄色冈.com赞AP.comP91| 欧美在线精品一区二| 精品欧美一区二区在线看| 欧美一区二区三区免费的| 老司机成人视频盒子| 视频一区二区精品中文字幕| 高速上的黄色情网战| 欧美精品一区二区三区…| 色大师二区不卡三区二区一日久…| 黄色国产一区二区三区| 黑人成人无码一二三区| 麻豆文化传播媒体入口| 色yeye免费视频在钱| 国产成+人+综合+亚洲| 国产亚洲一区=区三区| 黄色电影18wwwwwwwwwwwwwwwwwwwwwwwwwwwwwwwwwwwwwwwwwwwwwwwwwwwwwwwwwww | 美国美女在线一区二区| 韩国一区二区在线视频| 色一区二区最新地址| 欧美成人猛片在线观看网站免费视频下载 | 精品秘一区二三区免费雷安胖子 | 美国一级片软件下载| 欧美一区二区三区夜夜| 亚洲成人网站免费看| 国产欧美一区二区精品性色超碰| 欧美一区二区三区爽大酷| 片多多一区二区三区| 欧美色妇app下载| 精品秘一区二三区免费雷安胖子| 粉嫩黄牛一区二区三区| 欧美日韩在线一区二区| 欧美一区二区三区深喉| 国产殴美一区二区三区| 亚洲字幕欧美色不卡一区二区三区| 欧美国产福利一区合集| 欧美影院免费亚洲一区二区| 韩日美精品一区二区| 欧美一区二区三区男女性| 国产无人区卡一卡二卡三网站| 色色视频下载网站网址| 欧美黄色胖子网站专区| 欧美日韩亚洲另类综合体| 男人露jiji秘免费视频网站| 欧美精品一区二区潮喷| 亚洲成人小说在线一区| 美国成人精品一区二区| 2025国产一区二区三区无码| 美国一区二区在线观看| 欧美一区二区三区最新网址| 欧美一区二区三区在| 高清无码外国一级一区二区| 欧美激情一区二区三区同女同性……| 国产免费一区二区三区三洲老师视频| 白白发布免费在线播放视频| 福利一区二区及三区| 亚洲成人观看APP下载网址| 麻豆传煤网站APP入口直接进入免费版| 欧美成人精品一区字幕| 看免费毛片真人真做| 国产成人A片免费下载| 综合久久久久综合综合久…| 欧美日韩中文字幕组| 色婷婷丁香五月婷婷| 亚洲成人在线免费观看网站| 国产伦精品一区二区三区妓女下载| 本日本一道本一二三区兔费一本道不卡视频高请一区曰本 | 神木丽AV无码破解在线| 国产真人做爰在线视频| 欧美老妇精品一区二区| 男人露jiji秘免费视频樱花| 欧美播放器一区二区| 美国精品毛毛片一区二区| 麻花传媒剧国产MV在线观看| 男人天堂手机在线版| 金8天国一区二区三区| 欧美精品一区二区jsjdhfhdjsk| 欧美一区二区三区中文子幕| 欧美色区,一区二区三区| 国产123区m3u8| 欧美一区二三区人人喊爽| 麻花豆剧国产mv免费| 欧美肥美成人无码一区| 苹果国产成人视频| 亚洲愉拍一区二区三区| 亚洲影音先锋一区二区三区| 欧美日韩亚洲另类综合体| 欧美熟女一区二区视频| 色窝窝精品无码一区二区三区| 欧美一区二区三区精海角| 欧美性猛交一区二区| 欧美激情在线一区二区| 激情欧美一区二区三区| 白嫩漂亮一区二区迅雷下载| 麻豆传媒,亚洲一区| 亚洲无码中文日韩人妻2025| 男男被爽到翻白眼网站| 美女的隐私秘部位网站免费| 欧美日本大本道一二三区| 色五月色婷婷丁香综合| 欧美日韩一区二区一卡二卡| 窝窝熟女超碰一区二区| 色狠狠综合一区二区| 色偷偷欧美一区二区三区| 色欲综合欧美一区二区三区| 欧美色影院极品一区| 欧美日韩一区二区在线观播放 | 欧美一区二区三区哆哆| 鲁丝一区鲁丝二区鲁丝三区 | 欧美日韩一区二区不卡我| 欧美精品一区二区三区日区 | 狂野欧美一区二区三区四区| 白嫩漂亮一区二区迅雷下载| 国产又爽又黄免费| 香蕉97超级碰碰一区二区三区| 欧美在线一区二区三区四区 | 亚洲成人第一网站免费| 欧美美女精品一区二区| 2025国产精品免费一区| 歐州歐美一區二歐三區免费| 黄色成人一区二区三区| 黄色网一区二区三区| 麻豆视传媒短视频网站-入口2021仙踪林 | 色噜噜AV***一区二区 | 美女黄网站色大免费观看| 能免费看的国外最大的成人网站 | 麻豆文化传媒官网最新| 国产欧美区精品二区| 国产日韩欧美二区三区| 鲁丝成人一区二区三区影院 | 2025av久久久精品中文| 精品一区二区十八禁蜜桃| 香蕉久久一区二区三区| 精选欧美一区二区视频| 欧美激情视频一区二区三区福利 | 亚洲成人福利宝藏导航| 老牛视频一区二区三区| 美女免费的隐私网站| 欧美性爰一区二区三区| 亚洲射精品午夜射精韩日| 精品卡一卡卡2卡3网站 | 欧美金发大战一区二| 亚洲成人福利宝藏导航| 草莓导航-福利导航| 欧美性爱一区两区三区| 欧美一区二区三区四区五区〖网: 欧美一区二区三区四区五区〖网:.〗 | 韩日韩一区二区三区| 亚洲影院一二三区澳洲| 欧美黑白配一区二区三区| 国产日本欧洲亚洲一区| 草莓AV福利网站导航| 欧美激情在线观看亚洲一区| 黄色免费app欧美| 欧美淫荡一区二区三区四区五区| 欧美一区二区三区不卡黄片| 激情欧美国产一区二区| 激情欧美一区二区三区黑长吊牛牛影视| 欧美精品不卡一区二区三区 | 精品秘无码一区二区三区老师苹果| 国产成人+综合亚5| 蜜桃迅雷下载一区二区三区| 欧美激情爆操骚逼精品区| 蜜桃二区三欧美一区二区mo| 欧美国产精品三级一区| 蜜桃久久久亚洲精品久久| 国产精品一区二区外| 欧美激情在线一区二区| 国产一区福利导航| 鲁大师无码人妻一区| 欧美一区二区三区夜夜嗨| 欧美的一区二区视频| 美园和花一区二区三区| 色情app在线观看| 肉博团两个女人的高潮| 2025久久国产精品网址https://| 欧美激情在线片一区| 精品一二区三区四区| 国产欧美一区二区三区视频明星换脸 | 黄色.comsjfh| 网站欧美XXXXX| 麻豆剧传媒精品一区二区| 黄色大香蕉APP网站| 葡萄网站中文字幕一区二区| 色吧亚洲色欧美色一区二区三区| 欧美日韩123区不卡| 欧美一区二区三区少妇调教| 亚洲影音先锋一区二区三区| 亚洲天堂诱惑夜福利| 黑人AV一区二区三区| 潮逼成人污视频网站| 欧美精品XXXX一区二区免费看| 黄色小说成人电影在线免下载 | 真人性做爰A片7788软件| 欧美极度虐待一区二区| 香蕉av久久一区二区三区| 黑人巨大精品欧美一区二区三区色欲 | 亚洲成人AV免费播放器| 国产成人精品一区二区三免费| 国产一区二区欧美日韩| 蜜桃臀欧美精品一区二区| 欧美成人二区三区三区| 谷露大香蕉一区二区| 欧美一区二区三区四区五区在干嘛呢?| 福利撸视频一区二区三区| 欧美激情一区=区三区| 国产亚州欧美一区二区三区| 男人吃奶摸下挵进去有味道吗 | 网站你懂我的意思吧在线观看下载 | 男人天堂网在线观看| 亚洲成色在线综合网| 国产做受高潮肉博团| 殴欧美亚一区二区三区| 国产欧美一区二区色老头| 精品成人亚洲中文字幕| 欧美成人社一区二区| 精品秘一区二三区胖子| 亚洲成人性爱一区二区| 色窝窝无码一区二区三区2022| 海角社区视频在线观看| 黄色片成人网站免费| 欧美精品一区二区色多多香蕉| 欧美一区二区三区性| 海角社区视频在线观看| 粉嫩一区二区三区四区五区| 亚洲成色一区久久久| 综合网婷婷成人综合网| 国产成人综合老少配| 麻豆传文化传媒网站入口免费| 欧美国产激情一区三区| 精品蜜桃一区二区三区| 迅雷下载一区二区| 2021亚洲卡一卡二新区| 精品免费产品2023最新| 逗比导航福利国产视频精彩对白露脸一区二区 | 综合欧美日韩一二三四| 香蕉av网一区二区| 欧美一区二区三区在线免费| 欧美精品一区二区蜜臀亚洲| 欧美美激情一区二区三区| 国产成人秘在线播放| 麻豆国产传媒一区二区| 色呦呦在线播放视频| 欧美国产日韩精品二区四区| 黄网站免费下载观看| 欧美一区二区三区免费视频播放器| 欧美重口另类女奴一区| 白嫩漂亮一区二区迅雷下载| 色呦呦欧美二区三区五区| 韩国日本欧美视频二区| 色老头在线视频福利|